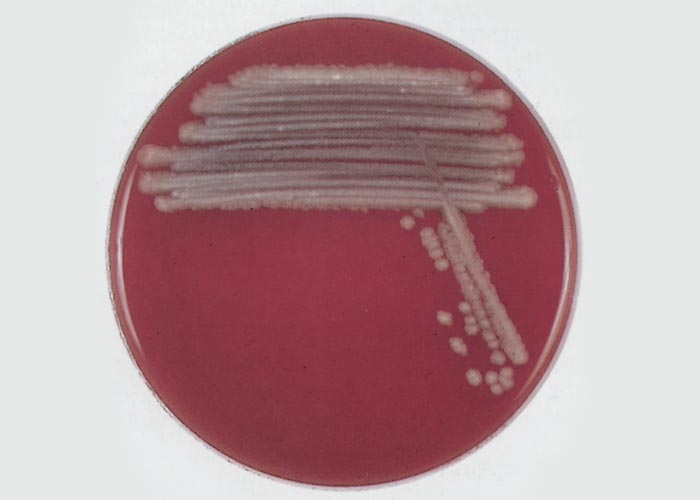
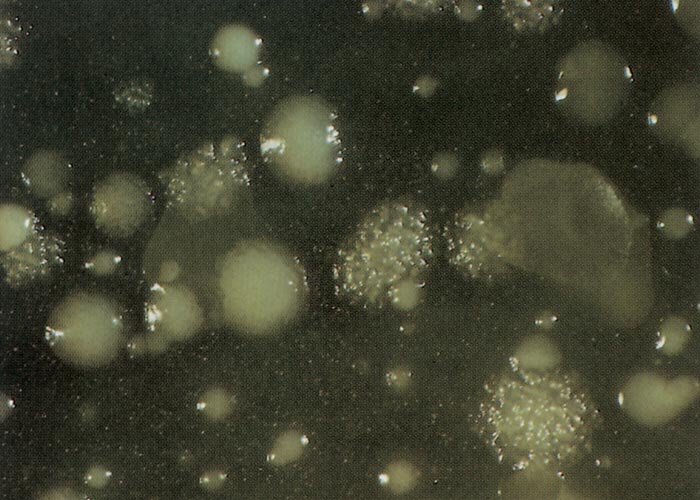
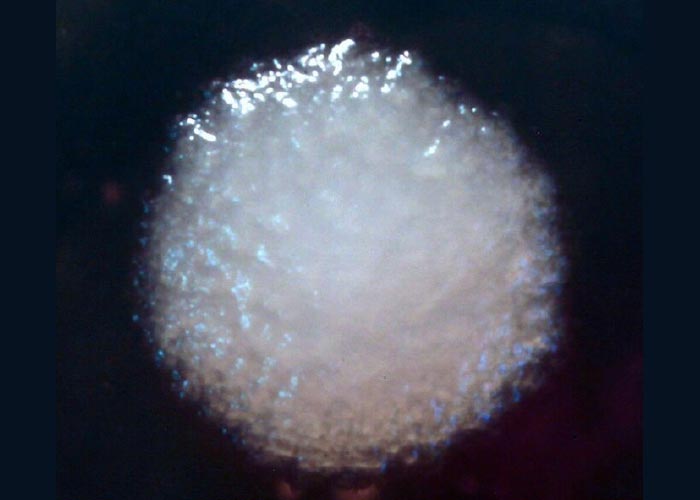
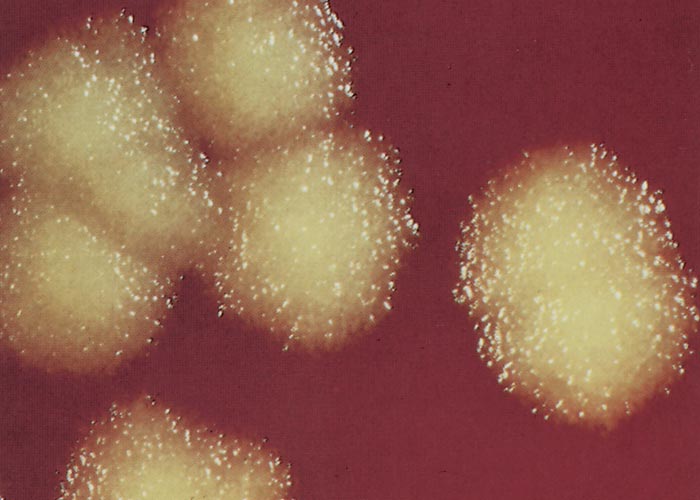
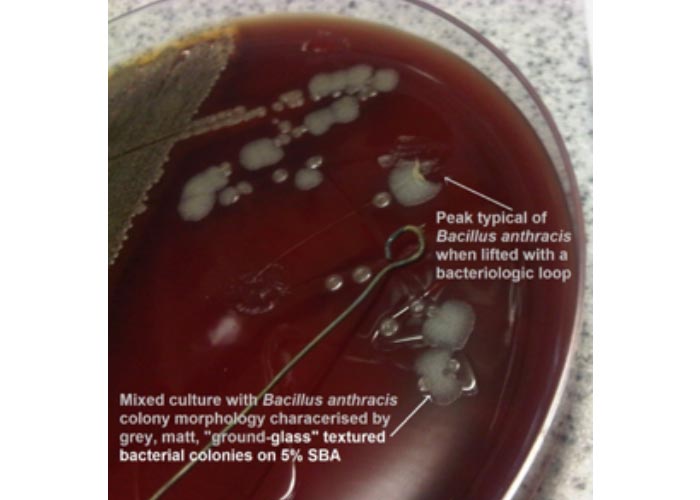

- Infectious Diseases of Livestock
- Part 3
- Anthrax
- GENERAL INTRODUCTION: SPIROCHAETES
- Swine dysentery
- Borrelia theileri infection
- Borrelia suilla infection
- Lyme disease in livestock
- Leptospirosis
- GENERAL INTRODUCTION: AEROBIC ⁄ MICRO-AEROPHILIC, MOTILE, HELICAL ⁄ VIBROID GRAM-NEGATIVE BACTERIA
- Genital campylobacteriosis in cattle
- Proliferative enteropathies of pigs
- Campylobacter jejuni infection
- GENERAL INTRODUCTION: GRAM-NEGATIVE AEROBIC OR CAPNOPHILIC RODS AND COCCI
- Moraxella spp. infections
- Bordetella bronchiseptica infections
- Pseudomonas spp. infections
- Glanders
- Melioidosis
- Brucella spp. infections
- Bovine brucellosis
- Brucella ovis infection
- Brucella melitensis infection
- Brucella suis infection
- Brucella infections in terrestrial wildlife
- GENERAL INTRODUCTION: FACULTATIVELY ANAEROBIC GRAM NEGATIVE RODS
- Klebsiella spp. infections
- Escherichia coli infections
- Salmonella spp. infections
- Bovine salmonellosis
- Ovine and caprine salmonellosis
- Porcine salmonellosis
- Equine salmonellosis
- Yersinia spp. infections
- Haemophilus and Histophilus spp. infections
- Haemophilus parasuis infection
- Histophilus somni disease complex in cattle
- Actinobacillus spp. infections
- infections
- Actinobacillus equuli infections
- Gram-negative pleomorphic infections: Actinobacillus seminis, Histophilus ovis and Histophilus somni
- Porcine pleuropneumonia
- Actinobacillus suis infections
- Pasteurella and Mannheimia spp. infections
- Pneumonic mannheimiosis and pasteurellosis of cattle
- Haemorrhagic septicaemia
- Pasteurellosis in sheep and goats
- Porcine pasteurellosis
- Progressive atrophic rhinitis
- GENERAL INTRODUCTION: ANAEROBIC GRAM-NEGATIVE, IRREGULAR RODS
- Fusobacterium necrophorum, Dichelobacter (Bacteroides) nodosus and Bacteroides spp. infections
- GENERAL INTRODUCTION: GRAM-POSITIVE COCCI
- Staphylococcus spp. infections
- Staphylococcus aureus infections
- Exudative epidermitis
- Other Staphylococcus spp. infections
- Streptococcus spp. infections
- Strangles
- Streptococcus suis infections
- Streptococcus porcinus infections
- Other Streptococcus spp. infections
- GENERAL INTRODUCTION: ENDOSPORE-FORMING GRAM-POSITIVE RODS AND COCCI
- Anthrax
- Clostridium perfringens group infections
- Clostridium perfringens type A infections
- Clostridium perfringens type B infections
- Clostridium perfringens type C infections
- Clostridium perfringens type D infections
- Malignant oedema⁄gas gangrene group of Clostridium spp.
- Clostridium chauvoei infections
- Clostridium novyi infections
- Clostridium septicum infections
- Other clostridial infections
- Tetanus
- Botulism
- GENERAL INTRODUCTION: REGULAR, NON-SPORING, GRAM-POSITIVE RODS
- Listeriosis
- Erysipelothrix rhusiopathiae infections
- GENERAL INTRODUCTION: IRREGULAR, NON-SPORING, GRAM-POSITIVE RODS
- Corynebacterium pseudotuberculosis infections
- Corynebacterium renale group infections
- Bolo disease
- Actinomyces bovis infections
- Trueperella pyogenes infections
- Actinobaculum suis infections
- Actinomyces hyovaginalis infections
- GENERAL INTRODUCTION: MYCOBACTERIA
- Tuberculosis
- Paratuberculosis
- GENERAL INTRODUCTION: ACTINOMYCETES
- Nocardiosis
- Rhodococcus equi infections
- Dermatophilosis
- GENERAL INTRODUCTION: MOLLICUTES
- Contagious bovine pleuropneumonia
- Contagious caprine pleuropneumonia
- Mycoplasmal pneumonia of pigs
- Mycoplasmal polyserositis and arthritis of pigs
- Mycoplasmal arthritis of pigs
- Bovine genital mycoplasmosis
- Neurotoxin-producing group of Clostridium spp.
- Contagious equine metritis
- Tyzzer's disease
- MYCOTIC AND ALGAL DISEASES: Mycoses
- MYCOTIC AND ALGAL DISEASES: Pneumocystosis
- MYCOTIC AND ALGAL DISEASES: Protothecosis and other algal diseases
- DISEASE COMPLEXES / UNKNOWN AETIOLOGY: Epivag
- DISEASE COMPLEXES / UNKNOWN AETIOLOGY: Ulcerative balanoposthitis and vulvovaginitis of sheep
- DISEASE COMPLEXES / UNKNOWN AETIOLOGY: Ill thrift
- Eperythrozoonosis
- Bovine haemobartonellosis
Anthrax
This content is distributed under the following licence: Attribution-NonCommercial CC BY-NC
View Creative Commons Licence details here
NJ Maclachlan and M-L Penrith (Editors). V De Vos, H Van Heerden and W C Turner, Anthrax, 2018.

Anthrax
Previous authors: V DE VOS AND P C B TURNBULL
Current authors:
V DE VOS - Private, BVSc, BSc (Hons), De Vos Landgoed/Estate(Pty) Ltd, Mbombela, Mpumalanga, 1200, South Africa
H VAN HEERDEN - Senior Lecturer, PhD, Department of Veterinary Tropical Diseases, Faculty of Veterinary Science, University of Pretoria, Private Bag X04, Onderstepoort, Pretoria, South Africa
W C TURNER - Assistant Professor, PhD, University at Albany, 1400 Washington Avenue, State University of New York, Albany, New York, 12222, United States of America
Introduction
Anthrax is a peracute, acute or subacute, highly contagious disease of domestic and wild animals and humans caused by the bacterium Bacillus anthracis. In most species of animals it is characterized terminally by the development of a rapidly fatal septicaemia, resulting in sudden death. The principal lesions are those of widespread oedema, haemorrhage and necrosis. An anthrax-like disease has been recorded in several mammal species in western and central Africa, caused by Bacillus cereus biovar anthracis.6, 179
Epidemics occur almost every year worldwide resulting in numerous deaths in animals and humans. 229 Martin (2010) estimated human anthrax cases globally to range between 2000 to 20000 annually. Humans are most often infected by exposure to infected animals or their products.
A global historical perspective
The first record indicative of anthrax is considered to be in the Bible (Exodus, Chapters 7 to 9), which refers to the fifth and sixth plagues of Egypt, this murrain, which is believed to be systemic and cutaneous anthrax respectively, occurred in about 1491 BC.100, 183, 192, 193, 312, 393 The next record was provided by Virgil (70 to 19 BC), who not only described major periodic outbreaks indicative of anthrax in animals and humans in ancient Rome, but also associated the occurrence of anthrax in humans with the consumption of meat or contact with hair or hides of animals that had died of the disease.92 Reference is also made to “anthrax” in the ‘Hippokratika’, a collection of veterinary documents dating from the tenth century.183 Earlier writings therefore pointed to the probable origin of anthrax being in erstwhile Mesopotamia and northern Africa.183, 192, 193, 312 While the Nile valley is the locality where the disease was first recorded its further spread was thought to be associated with the process of domestication of wild ungulates and the dispersion of domestic cattle into the rest of Africa,102, 120, 275 and subsequently into areas such as Eurasia,193 the USA,141, 319, 393 and Australia.295 It is, however, also possible that the native tribes and their domesticated animals, during their southern migrations through Africa, encountered anthrax along the way, where it already existed endemically among free-living wild animals. The genotypic grouping of anthrax isolates supports this hypothesis and suggests that the geographic origin of B. anthracis may be in sub-Saharan Africa. 171, 308
Phylogenetic methods have since been used to trace the prehistoric timing of B. anthracis diversification, and the introduction and spread of anthrax globally. 367 It is endemic in many regions of the world especially sub-Saharan Africa, Asia and Central and South America.391 Bacillus anthracis was estimated to have spread widely about 3000-6000 years ago although further evidence suggests this was an underestimation The earliest introduction into North America is estimated to have occurred around 13 000 years ago, entering from Asia via the Beringian Steppe ecosystem.174 Isolates from across China suggest that B. anthracis movement across Eurasia was associated with ancient trade routes along the Silk Road.302
The more recent history of anthrax is intimately associated with the history of microbiology and infectious diseases.183, 200, 312, 349, 394 Anthrax appears to be the first disease of humans and animals that was shown to be caused by a microorganism. Barthelémy in 1823 demonstrated its transmissibility by inoculation, and Rayer and Davaine in 1850 observed filiform bodies in the blood of animals that had died of the disease. This organism, referred to as Bacterium by Davaine in 1864, was named Bacillus anthracis by Cohn in 1875.64, 394 Final proof of its causative role was however furnished by Koch in 1876.190 In this classic masterpiece, subsequently referred to as ‘Koch’s postulates’, he described not only the organism, its ability to form resistant spores, and its cultivation in vitro, but also the reproduction of the disease by injection of pure cultures, and the recovery of the organism at necropsy from animals that had died as a result of experimental infection.190 Anthrax was also the first disease against which avirulent strains of the causative organism were used as immunizing agents in vaccines.266, 342
In spite of the fact that Pasteur’s 1881 vaccine against anthrax266 has long been credited with being history’s first bacterial vaccine, it has since been pointed out that Greenfield prepared an effective vaccine against anthrax and described his results some months before Pasteur’s experiments were conducted.100, 183, 192, 193, 312, 342 Pasteur’s vaccine however, met with disappointing results, and in 1920, the introduction of an improved attenuated spore vaccine, after the method of Cienskowsky, marked the turning point in the struggle against anthrax.149 This was later replaced by a more effective spore vaccine, prepared by Viljoen et al.371 which was extensively used until 1937, when it was superseded by the highly effective and successful Sterne spore vaccine, which is still in use today.328, 331-333
The pathogenesis of anthrax was extensively studied during the first half of the twentieth century,{326, 327, 349 and the successful application of penicillin therapy187, 250 lessened the concern about the disease. Successful vaccine and effective control measures led to a decline in the occurrence of anthrax as has been experienced in many countries throughout the world, with the disease approaching near eradication in a number of them.155 This has been ascribed to the availability of reliable vaccines (especially the vaccine developed by Sterne), the liberal use of antibiotics, and the implementation of quarantine regulations.388 There are, however, still a large number of countries where the situation has remained unchanged and severe epidemics still occur.156 In 1996 Hugh-Jones warned that surveillance procedures and reporting of anthrax are defective at all levels of development, which indicates a clear underestimation of the seriousness of the disease in a substantial number of countries. History has also shown that anthrax remains a potential danger in many regions of the world should anything happen to upset recognized practices of hygiene and control.330, 349
Because of practical difficulties encountered in vaccinating free-living wild animals, anthrax retains a continued place in the ecology of free-ranging wildlife in several regions of the world.55, 88 Major epidemics have been, and periodically still are, recorded in African wildlife conservation areas such as the Queen Elizabeth National Park in Uganda, the Selous Nature Reserve in Tanzania, the Luangwa Valley in Zambia, the Etosha National Park in Namibia and the Kruger, Kalahari Gemsbok and former Vaalbos National Parks in South Africa.55, 80, 85, 99, 100, 115, 213, 215, 270, 349, 353 In the Kruger National Park in South Africa and Etosha National Park in Namibia, a seemingly stable ecological endemic equilibrium, with anthrax an integral part of the system, has also been identified. It suggests a symbiotic relationship which could only have taken place over a long evolutionary history.157
Interest was re-awakened in a different context by the threat of B. anthracis being used as an agent in biological warfare, such as happened during World War II.63, 66, 227, 325 However, after the signing of the 1972 Biological Weapons Convention, interest in B. anthracis waned to the extent that the subsequent period, albeit short, has been referred to as a ‘dark age’ for research into anthrax.349 Since then an epidemic of anthrax in humans occurred near Sverdlovsk in Russia in April 1979, in a facility suspected of being utilized for the production of materials for use in biological warfare.20, 128, 233, 282, 365, 372 This caused international concern and appeared to violate the 1972 Biological Weapons Convention.128 Subsequent threats to use B. anthracis as an agent for biological warfare have been made as recently as 1990 during the Gulf War and afterwards as tension between Iraq, neighboring countries and the United Nations’ forces continued.101 Bioterrorism is also considered another potential area of misuse for anthrax.168 It was calculated that the economic impact of such an act in the USA could amount to $26,2 billion per 100 000 persons exposed.168 The total cost of the 2001 anthrax letter attack in the USA associated with decontamination was estimated to be $320 million.292 Biological warfare/terrorism, involving anthrax, and possible means to combat it, will therefore remain a concern for the international community in the foreseeable future and has rekindled interest in the disease from the standpoints of detection, protection and treatment.
A southern African historical perspective
In the light of present-day knowledge, a disease which undoubtedly was anthrax was documented in the records of early historians, explorers and travellers in southern Africa. As early as 1838, Alexander3 recognized and described a condition known as “blood sickness” in people partaking from the “impure flesh” of sheep at Henkrees, close to the “Gariep River” (now known as the “Orange River”, northern Cape Province, South Africa). He described the disease as a “corrupted state of the blood” and that “it appears in angry sores on the arms and on other parts of the body”.
It would also appear that, in 1842, the missionary Robert Moffat was the first to chronicle the disease in a human of European descent in southern Africa.244 He also described the disease as being particularly prevalent in humans and livestock of the indigenous tribes in the north-eastern Northern Cape Province in an area near the Kuruman Missionary Station. Dr Andrew Smith, director of an ‘Expedition for Exploring Central Africa’, which took place from 1834 to 1836, also very vividly describes in his diary, published in 1939, the clinical form of anthrax in humans and domestic animals.178 He called the disease either ‘bloodzichte’ or ‘quatsie’. At the time Smith was travelling through the Kuruman area.
In what can probably be considered to be the first record of the co-existence of anthrax in wild animal species, domestic animals and humans in southern Africa, Livingstone in 1857220 reported on a very virulent disease in the Marico district, which he called ‘horsesickness’, but which, from the description in his book, can now, without doubt, be identified as anthrax. He also reported on “great numbers” of “koodoo” (kudus), “gnus” (wildebeest) and zebras that died from the same cause. Commenting on the disease in humans he claimed220 that “when the flesh of animals that have died of this disease is eaten, it causes a “malignant carbuncle”, called”kuatsi” or “selonda” by the indigenous people and which, when it appears over any important organ, proves rapidly fatal”. He took this as “proof of the disease of the tame and wild being identical”.
As can be inferred from the accounts by Smith in 1834 to 1836,178 Moffat in 1842244 and Livingstone in 1857,220 the use of the term ‘kwatsi’ or ‘quatsie’ for a condition which was undoubtedly anthrax, was apparently in general use in the north-eastern part of the Northern Cape Province and adjacent parts of North West Province and Botswana at the time. In regions as far apart as Botswana and Lesotho, the term ‘kwatsi’ for the clinical form of anthrax is still in use today.48, 81 It suggests a high degree of familiarity with the disease on the part of the indigenous peoples of the north-central southern African region. This could only have been acquired after prolonged contact with it. It can, therefore, be taken as proof that the existence of anthrax preceded the arrival of the first Europeans in this part of southern Africa.
This hypothesis is further corroborated by the fact that virulent B. anthracis was isolated from bones collected at an archaeological digging of an early African settlement in the far northern regions of the Kruger National Park in the Mpumalanga and Limpopo Provinces of South Africa.83 These bones were subsequently radiocarbon-dated as being 200 ± 50 years old (i.e. AD 1770 ± 50), and can be considered as providing the earliest proof of the occurrence of anthrax in southern Africa.
While the first scientific report indicating the possible existence of anthrax in South Africa was made by Branford in 1876,39 the first official record of its occurrence in the country was that of Hutcheon in 1880.158 Anthrax was placed on the list of scheduled diseases in De Oranje Vrijstaat Republiek (present Free State Province) in 1891, and governmental control measures were instituted in the then Transvaal Province (Northern regions of the South Africa) in 1903.149
Prior to 1904, anthrax spread slowly from its apparent original locus, and there was a tendency to confuse anthrax and horse sickness.150, 158, 169, 201 In spite of the fact that, by 1905, anthrax had extended beyond the borders of this locus to include larger areas of the north-eastern Northern Cape, the western North-West and parts of the Free State provinces, it was still regarded as being ‘a very insignificant item in the catalogue of South African diseases’.335, 336 Thereafter, however, outbreaks escalated exponentially (Figure 1). Around the time of Union in 1910, Gray133 repeatedly referred to the increasing prevalence of the “scourge”, while Dixon warned that, unless more stringent measures were taken to control the disease, it was likely to become much more serious.93 Dixon’s prediction was realized and, by 1923/24, the disease had not only spread into new districts, but had also become markedly more prevalent (Figure 1). During 1923, the year during which its prevalence peaked in South Africa, it was estimated that 30 000 to 60 000 animals had died of anthrax.330
In 1882, Pasteur’s vaccine was introduced into South Africa, but met with disappointing results. In 1920, the introduction of an improved attenuated spore vaccine, after Cienskowsky, significantly improved anthrax prevention in South Africa.149 This was later replaced by a more effective spore vaccine, prepared by Viljoen et al.371 which was extensively used until 1937, when it was superseded by the Sterne spore vaccine. The decision by the Government to issue vaccine free-of-charge to all stock owners in South Africa in 1923 was followed by an immediate and drastic reduction in the number of outbreaks of anthrax (Figure 1). From 1945, when compulsory inoculation of cattle became a legal requirement, a further decline in reported outbreaks resulted, with smaller point outbreaks remaining mainly in the Kruger and Gemsbok National Parks and Northern Cape province.80, 143 Information provided by the South African Department of Health reflects a similar decline in the prevalence of anthrax in humans in South Africa, reflecting the well-established relationship between the occurrence of the disease in animals and man.
The history of anthrax in Namibia mirrors the patterns observed in South Africa. The disease was first described occurring in Herero people and their livestock from 1879, a year described as “Otjindimba” – the year of the “anthrax pox”.99, 100 Sporadic anthrax outbreaks, with occasional large outbreaks in humans and livestock, were recorded in central and northern Namibia over the period from 1884-1940s; thereafter vaccination campaigns reduced its impact on humans and livestock.99, 100 Less is known about the history of anthrax in Namibian wildlife, because wildlife did not contribute significantly to the economy and thus mortalities were not reported.100 Early reporting of anthrax in wildlife was in areas with contact between wildlife, livestock and humans in farming regions. Anthrax was first diagnosed in wildlife in Etosha National Park in 1964, although large die-offs of herbivorous wildlife were observed in years prior and attributed to various other causes.100 Large anthrax outbreaks in wildlife were recorded in Etosha 1968-1972, attributed to game management practices including placing boreholes in the endemic anthrax area and fencing the park boundaries, both of which caused otherwise migratory herbivores to remain in this area year-round.100 Closing of watering points on the grassland plains north of Okaukuejo in central Etosha lessened the severity of these outbreaks. Despite vaccination efforts, anthrax remains endemic in Namibia and outbreaks are regularly recorded in wildlife and livestock.18
Aetiology
Bacillus anthracis is a bacterium belonging to the family Bacillaceae.64 The genus Bacillus includes many species which have a great diversity of properties, but which are all aerobic and spore bearing. Before 1950, the taxonomy of the aerobic spore-bearing bacteria was in a state of confusion. However, 310, 311 brought some order into the taxonomy of the genus Bacillus, to which noteworthy contributions have been made by Wolf and Barker (1968),396 Gordon (1973; 1981),129, 130 Gordon et al. (1973),131 Gibson and Gordon (1974),118 the Subcommittee on the Taxonomy of the genus Bacillus (1980),4 and Berkeley and Goodfellow (1981).17 Spores, an essential link in the dormancy and germination of B. anthracis, and therefore its survival, are discussed by Sussman and Halvorson (1966).337 The works of Parry et al. 194, 265 provide excellent reviews of the taxonomic interrelationships of those members of the genus Bacillus which have some clinical significance. The taxonomic status of B. anthracis as a homogeneous species, distinct from B. cereus, B. mycoides and B. thuringiensis, has been confirmed by using DNA-DNA hybridization techniques.31, 284 Using a PCR technique, Henderson and co-workers concluded that isolates of B. anthracis are almost completely homogeneous, indicating a clonal lineage, and are distinct from other members of the B. cereus group.146, 147 Henderson146 also speculated that B. anthracis, as a species in its own right, may have evolved only relatively recently from a B. cereus-like precursor. The close taxonomic relatedness of these species has been covered by Turnbull et al.357
Actively growing (vegetative) B. anthracis organisms are typically rod-shaped, measure 1,0–1,5 × 3,0–10,0 µm and, in stained smears of blood or tissue fluid obtained from infected animals, the organisms appear truncated, commonly occur singly or in short chains. The vegetative cells of B. anthracis survive poorly outside the animal host. In contrast, the spores, which form rapidly under suitable conditions, are very resistant and can withstand adverse environmental conditions for considerable periods.30, 337 In unstained culture preparations, the organisms are non-motile rods and, in contrast to those in animal tissues, have rounded ends.234 In vitro, B. anthracis grows in long, undulant chains composed of many individuals, which resemble the segments of a bamboo pole. In broth cultures these strings of cells result in characteristically flocculent growth. Nutrient broth, when inoculated with B. anthracis becomes turbid, and when the floccules become more dense they sediment to the bottom.
Bacillus anthracis is generally Gram-positive, but this attribute may be lost with ageing of the culture.118 Gram’s staining of smears of the organism grown in culture should therefore be carried out as soon as possible, usually within 24 hours of the commencement of growth. Bacillus anthracis vegetative cells are surrounded by a well-developed capsule (Figures 2 and 3). Capsules are not formed in culture unless special conditions for their development are provided. Special conditions includes a high partial pressure of carbon dioxide, incubation under 5 to 20 per cent carbon dioxide atmosphere, media containing serum,326 or bicarbonate,123, 341 or activated charcoal with or without serum,235 or milk.379 Capsule formation in bicarbonate agar is considered to be an effective way of differentiating between B. cereus and B. anthracis.283
Several Bacillus spp., including B. anthracis, B. subtilis, B. licheniformis and B. megaterium under appropriate growth conditions, also produce capsules containing varying amounts of the polypeptide, poly-D-glutamic acid. In contrast to the polysaccharide capsule of other bacteria, the capsule of B. anthracis consists of poly-D-glutamate and shows up well with polychrome methylene blue (M’Fadyean reaction stain) especially using pure azure B,263 reasonably well with Wright’s and Giemsa (Figures 3 and 4) stains and a 0,1 per cent toluidine blue solution in a 1 per cent aqueous solution of alcohol.265 This staining reaction is so typical that demonstration of the capsule by staining blood smears is accepted as diagnostic for anthrax. Other Bacillus spp., such as B. subtilis, B. licheniformis and B. megaterium, can also produce capsules that contain polypeptides which impart similar staining characteristics. These species are, however, unlikely to be encountered in specimens of blood or tissues from animals or humans suspected of having anthrax.
The spores are ellipsoidal or oval, and are formed equatorially without causing a swelling of the sporangium. Spores develop on exposure of the vegetative cells to atmospheric or dissolved oxygen, and are liberated by lysis of the bacilli. They germinate by polar rupture. Sporulation, in cultures on the surface of solid media, commences at about the end of logarithmic growth and, at temperatures of about 30 to 38 °C, is far advanced by 24 hours, and usually complete by 48 hours.221 As with other members of morphological Group 1 Bacillus species,129 the shape, position and size of the spores relative to the sporangium are important criteria in the taxonomy of the genus Bacillus, and are of considerable assistance in distinguishing B. anthracis from other members of the genus. The aerobic spore-bearers were first classified into three distinct, morphological groups on the basis of these criteria.129, 265, 310, 311 Bacillus anthracis is placed in Morphological Group I (absence of sporangial swelling, and ellipsoidal spores). Other Bacillus spp., such as B. megaterium, B. cereus, B. cereus var. mycoides, B. thuringiensis, B. licheniformis, B. subtilus, and several others, however, also possess these characteristics; consequently other methods must be used to differentiate between them.265
Although the spores of B. anthracis can be stained by the usual spore stains, Schaeffer and Fulton’s malachite green or modified Ziehl-Nielsen techniques are recommended.265, 347, 391 Relief methods, which leave the spores uncolored, are sometimes useful. The use of phase contrast microscopy is also helpful in the examination of spores, especially in the preparation of maximally dormant spores as, for example, in the production of vaccines.
The optimum temperature for growth of B. anthracis is between 35 and 37 °C. It utilizes simple sources of nitrogen and carbon for energy and growth, and grows on most of the ordinary culture media, but the provision of suitable concentrations of thiamine and metallic ions, particularly potassium, magnesium, calcium, iron and manganese, is important.42, 52, 185, 276 After 24 hours’ growth on nutrient agar, the colonies are 3 to 5 mm in diameter and have a grey, frosted, “cut glass” appearance, which is best viewed under a stereoscope with the light source at an oblique angle from above (Figures 5 and 6 a to c). The margins of colonies may be irregular because of highly tangled outgrowths of bacterial filaments from the edges, which impart the so-called Medusa head appearance (Figure 7). Typically these outgrowths taper and recurve in the same direction so that the colony as a whole almost appears to be spinning. This feature is best demonstrated by placing a cover slip on top of a young colony growing on an agar surface and examining the edges under a microscope using a x10 objective lens. This appearance is however also seen in colonies of many strains of B. cereus, B. thuringiensis, B. mycoides265 and B. megatherium170 although the recurvature of the outgrowths of B. cereus colonies is less noticeable than that which can be seen in the other Bacillus spp.235 By drawing a bacteriological loop across a colony, growth can be made to stand up perpendicular to the agar surface without support.109 This form of growth is probably responsible for “spiking” or “tailing” along the inoculation line which, in turn, is associated with virulence as avirulent strains tend to lack these outgrowths.236 After 24 hours, growth is less characteristic and colonies become whitish-opaque and contain scattered darker lacunae. Colonies are then also typically butyrous, lacking the tenacity of young growth, and are easily emulsifiable.
Figure 6a to c Bacillus anthracis colonies with magnification showing grey colonies with ground-glass appearance.
In gelatin stab cultures, delicate lateral projections grow out of the needle tract, with the longest projections at the upper part of the culture and the others decreasing in in length progressively downwards, giving the growths an inverted fir tree effect. Liquifaction is slow and crateriform. This has some diagnostic application as B. cereus has a more pronouncedarborescent, filamentous growth and causes liquefaction.
The main virulence factors for Bacillus anthracis are encoded by two plasmids with pXO1 encoding the tripartite protein exotoxin (PA, EF and LF) and the smaller pXO2 encoding the poly-D-glutamic acid capsule.107, 224, 267 The absence of either pXO1 or pXO2 will result in attenuation of the organism.107, 134, 224, 267, 381 PXO1 produces a tripartite extracellular toxin consisting of three distinct, relatively unstable protein components known as oedema factor (EF), protective antigen (PA), and lethal factor (LF).14, 111, 175, 206-208, 307, 317, 325 The PA combines with EF to produce oedema toxin (ET) and PA combines with LF to produce lethal toxin (LT).317 The PA functions as the non-toxic cell binding ligand responsible for transporting the toxic factors of LF and EF into host cells.65 Crucially, the PA is particulary responsible for the production of toxin neutralizing antibodies and protection against anthrax has been attributed to immunity against PA.107, 271, 380 Thus, EF is not toxic when given alone, but when mixed with purified PA and applied to the skin of rabbits, it causes oedema, and is nonlethal to mice when injected alone or mixed with EF and only lethal when mixed with PA.210 Oedema factor is an adenylate cyclase which is considered to be the archetype of a novel category of bacterial toxins.206, 207 Its activation requires the synergistic presence of PA, whereas LF blocks its action. Conversely EF also blocks the action of LF.210 It is hypothesized that PA binds to receptors on eukaryotic cells to create a receptor recognized by EF and LF.170
The plasmid PXO2, is involved in the synthesis of the anti-phagocytic poly-ɣ-D-glutamic acid (PGDA) capsule which protects the bacteria against phagocytosis, or consumption by defensive cells of the immune system.134 Various studies have shown that without its capsule, the bacteria can be phagocytized and destroyed.165, 225, 338 Attenuated strains that lack either of the plasmids have a reduced virulence. In the past bacilli which resemble B. anthracis but which failed to produce the capsule or to induce anthrax in animals have been dismissed in clinical and veterinary laboratories as B. cereus or simply as unidentified Bacillus spp. and discarded as inconsequential. However, the application of a DNA probe, polymerase chain reaction and specific toxin antigen revealed that a proportion of such strains are actually B. anthracis which lack the plasmid carrying capsule gene (pXO2).348
Mutants, or Pasteur strains, either arise spontaneously or can be induced in culture and may differ considerably from the wild type of B. anthracis. Pasteur266 in 1881 showed that B. anthracis loses much of its virulence permanently and irreversibly when cultivated at 420C for two or more weeks, and that these colonies are smoother and more glistening than those of the virulent type. Sterne,326 however, showed that wild, virulent strains are always smooth, mucoid and fully capsulated on serum agar under a moderately high partial pressure of CO2, and that the mucoid outgrowth upon further incubation consistently gave rise to uncapsulated, avirulent mutants which retain, to a high degree, the ability to elicit immunity to anthrax. Such a noncapsulated, spore-forming, immunogenic variant of B. anthracis forms the basis for the Sterne vaccine, which is the safest, most effective vaccine currently available for the prevention of anthrax in livestock.
Genomic diversity
Keim et al.171 developed genotyping grouping using multilocus variable tandem repeat assay (MLVA). (Figure 8) Initially MLVA8 loci identified two dissimilar groups (clade A and B). Isolates in clade A are found worldwide and are responsible for most epidemics and outbreaks , whereas clade B strains are geographically restricted, consisting of Kruger B which is exclusively restricted to southern Africa and B “CNEVA” identified in France.171, 308, 367 However, the resolution achieved with the MLVA8 was found to be limiting.173, 217 resulting in the MLVA15 used in combination with canonical single nucleotide polymorphisms (canSNPs).172, 367 The canSNPs on its own have limited resolving power but can be used to define the main clades and key phylogenetic positions within the clades.367 The MLVA15 divided the B. anthracis isolates into three major clades, namely clades A, B and C. The clade C isolate is also a restricted scale clade found in North America.271, 367 Le Fleche et al., 2001203 extended the assay to MLVA25 using gel electrophoresis rather than capillary electrophoresis making the MLVA25 more accessible by using basic equipment. The MLVA25 loci enabled the description of two new clades (D and E). Clade D was composed of an isolate of unknown origin and another from Italy, while the E (equivalent of Aβ) clade was composed of isolates from West Africa (Chad, Cameroon and Mali).25, 217, 223 These novel West African B. anthracis strains are anthrose deficient (endospores expose a pentasaccharide containing the anthrose monosaccharide) unlike other B. anthracis strains.340 In these West African countries animals are immunised with locally produced vaccine based on anthrose-positive spores of the B. anthracis Sterne strain.Tamborrini et al (2011)340 speculated that the anthrose-positive Sterne vaccine might not provide protection for animals against the anthrose deficient B. anthracis strains present in these West African countries.
More recently the MLVA15 and MLVA25 were combined into MLVA31.18 High throughput sequencing gives the best resolution, and SNPs retrieved from whole genome sequences facilitates high-resolution strain tracking. Canonical SNP typing and whole genome comparisons of multiple strains are now becoming the reference method in B. anthracis genotyping.40, 122, 177, 219, 287
Figure 8 Summary tree adapted from listed references of Bacillus anthracis MLVA clusters A, B and C with major subclades (Aa1, Aa2, Aa3, Aa4, Ab, B1, B2 and C in blue) represented by triangles. The single nucleotide polymorphism (SNP) lineages and sublineages are indicated in green. The D and E clades identified by Lista et al (2006)217 group in Aβ clade (Ancient A).217, 223, 271, 287
Epidemiology
Although there has been a progressive global reduction in livestock cases in response to national control programmes, anthrax still occurs virtually worldwide.156, 354 Surveillance and reporting are however defective in many countries at all levels of development, and the mere absence of the reporting of livestock anthrax does not necessarily mean that a country is free of the disease.156, 354 It is however considered uncommon in most of western Europe, Canada, the USA and Australia, and relatively common in southern and eastern Europe, several former USSR countries in Central Asia, southern and central America and Africa.156, 354, 367
With good disease surveillance, reporting and control, outbreaks of anthrax in domestic stock are usually of short duration and rarely progress beyond the primary cases which contracted the disease from a common source. Effective control measures instituted at an early stage usually result in the abrupt termination of outbreaks, giving rise to typical ‘point epidemics’. However, if disease surveillance, reporting and control of anthrax are inadequate or nonexistent,354 outbreaks may progress beyond the primary cases into major epidemics, such as occurred in Lesotho in 1994.81 This can occur in countries at all levels of development, even in the USA156 and Australia.112 As countries become free of anthrax and outbreaks are observed only rarely, the numbers of animals affected in an outbreak can increase, a phenomenon ascribed to the decreasing veterinary experience in recognizing cases and in dealing appropriately with outbreaks.352
Once an infected animal has died, the carcass site becomes a potential site of infection for the next host. The initiation of an outbreak includes interrelated factors such as specific properties of the bacterium; environmental factors promoting sporulation and survival of the pathogen, environmental factors altering host-pathogen contact rates, host density and host susceptibility; factors affecting dissemination of the organism from a carcass; and certain human activities (Figure 9). In anthrax, the abilities of the bacterium to survive outside its host, to contact, enter and successfully infect its host, and to multiply in vivo, are of particular importance.
The characteristic terminal septicaemia, which is a constant feature of the fatal disease in most animal species, ensures persistence of the disease. Sporulation starts towards the height of logarithmic growth, but only in the presence of sufficient oxygen. Sporulation occurs mostly after an infected fresh carcass has been opened and the tissues have been exposed to the surrounding oxygen in the air.345
The clotting ability of the blood of an animal suffering from septicaemic anthrax is impaired.71 This often results in the formation of pools of blood and tissue fluid in and around the carcass of such an animal. Bacillus anthracis vegetative cells appear to be rather ‘fragile’ and require protein at a protective concentration around them to prevent lysis. It is therefore a race against time to become sporulated before the protein (blood or serum) becomes diluted, dispersed or desiccated.
The number of B. anthracis spores produced from a carcass depends on the body size and terminal bacteremia of the host, and the nature and composition of the environment.215 Ambient temperature determines how long it will take for vegetative cells to “sporulate or die.”391 Vegetative bacilli have been considered poor competitors with putrefactive organisms, such that cells should die prior to sporulation if a carcass remains unopened by scavengers for longer than three days at temperatures of 25 to 30 °C or higher.320 However, an experimental study with plains zebra anthrax carcasses in Etosha National Park (with daily maximum temperatures within or exceeding this range) demonstrates that B. anthracis continues to sporulate for more than four days after host death, with or without being opened by vertebrate scavengers.15 Vegetative bacilli further survive in, and can be isolated from bone marrow for at least a week, and in skin for two weeks after death.238 At temperatures of 5 to 10 °C, the rate of decomposition of a carcass is reduced, and vegetative B. anthracis can still be recovered from it for up to four weeks after death.387
In cold climates, the temperature can be unfavourable for sporulation for much of the year,330 and its occurrence in some outbreaks in cold climates has been associated with human activities, such as importation of fodder and feed supplements originating from endemic anthrax areas.41, 163, 239 However, B. anthracis outbreaks in wood bison (Bison bison athabascae) in northern Canada,255, 289 or in reindeer (Rangifer tarandus) in northern Russia are not associated with human introductions. In July 2016, outbreaks were reported in reindeer (2600 cases) and humans in a district of the Russian Federation, where no anthrax has been reported since 1941.106 These outbreaks in reindeer on the Yamal Peninsula have been linked to B. anthracis from historical outbreaks being released from thawing permafrost.281 Thus B. anthracis is able to be maintained in the environment, even in very cold climates, though what effect differences in climate have on the timing or intensity of anthrax outbreaks is as yet unknown.
After spores are formed, a variety of factors may affect their survival, such as climate, soil composition, other microbes, certain chemicals and plant materials.55, 329, 394 In certain soils, the duration of the survival period is probably limited to not more than three or four years,387 whilst in other circumstances spores are found to remain dormant and viable in nature for at least 50 years227 or even 200 ± 50 years.83 In the dry state under laboratory conditions, they retain their viability and pathogenicity for at least 60 years.231, 297, 304, 395 Mobilization of enzymes in a calcium-rich lattice in the core of Bacillus spores is thought to be responsible for metabolic dormancy of the core and maintenance of germinability.257, 318 It is proposed that, in calcium-rich environments, exogenous calcium buffers leaching of calcium from the lattice, thereby enhancing preservation of the spores until optimal nutrients and conditions for outgrowth are present.96
Spore survival is best supported in alkaline, calcium-rich soils.154 Knowledge of the soil and climate conditions allowing long-term persistence of B. anthracis spores in the environment has been used to develop ecological niche models, to describe the conditions in which anthrax outbreaks occur, and to use those to predict the potential range of the disease’s distribution.12, 21, 22, 24, 167, 247 These models are not yet able to predict the distribution of B. anthracis over large spatial scales,248 indicating that there are additional features of the pathogen, hosts, or environments, yet to be described, that alter the pathogen’s niche from one region to the next.
Spores remain in a dormant state until germination is induced. Favourable conditions for dormancy are therefore those which will not readily induce germination, such as areas of low biotic turnover. Once germination is induced, the fragile Bacillus will die in a hostile environment, but will grow and multiply if conditions are favourable. Germination of B. anthracis spores occurs at temperatures between 20 and 40 °C at a relative humidity greater than 80 per cent.73, 343
Anthrax carcass sites are the primary sources for future infections.362, 363, 391 Experimental lethal doses (LD50s) vary among the transmission routes, with LD50s around 104-105 for inhalational anthrax,13, 339 and around 105-107 for the less deadly gastrointestinal anthrax.363 LD50s are not known for cutaneous anthrax. At natural (unmanaged) anthrax carcass sites, presence of the carcass alters the local environment in a way that facilitates transmission events. A study of zebra carcass sites in Etosha National Park demonstrated how nutrients from carcasses fertilize soils, supporting the growth of higher biomass and more nutritious grasses, that attract herbivores to these sites for foraging.361 Zebras in particular were up to four times more likely to feed on grasses at an anthrax carcass site than on grasses at a nearby control site.361 This attraction to carcass sites only persisted for one to two years after host death, when spore concentrations in soils are at their highest.363
Most of the spores remain at the site of the dead animal, but some are dispersed by scavengers (mammals, birds, and insects) by water run-off, and/or by humans.26, 80, 95, 215 Whether or not dissemination of spores from carcass sites is important for transmission depends inter alia upon the numbers of spores transported to new locations.
The role of scavengers in anthrax outbreaks is under debate, regarding whether the consumption of anthrax carcasses by scavengers leads to more or less environmental spore contamination, and if scavengers disperse the pathogen over long-distances. An experimental study excluding vertebrate scavengers from anthrax carcasses for four days after death found no significant differences in spore concentrations in soils at sites with or without vertebrate scavenging.15 The authors attributed the lack of difference between treatments to two potential causes: bloating of unscavenged carcasses causing ruptures to the skin that projected bacilli from the carcass allowing sporulation to occur and/or exclusion of vertebrate scavengers causing an increase in the density of invertebrate scavengers (blowflies) at carcasses. Depending on rates of scavenging, consumption of contaminated meat prior to sporulation would result in death of vegetative cells in the gut of scavengers. Large scavengers may dismember and move around the carcass during consumption, that could lead to spore contamination over a larger area, or it could reduce the concentration at any specific area sufficiently to prevent future lethal contacts. This implies that, on the one hand, scavengers may disseminate the pathogen, yet, on the other, they may curtail its spread by their ability to locate carcasses shortly after death and minimize contamination by the rapid consumption of carcasses before most of the vegetative cells have had time to sporulate.79, 215 Further research is required to determine the conditions under which scavenging of anthrax carcasses may lead to greater or lesser changes of anthrax transmission.
Vultures are often implicated in transporting B. anthracis spores from anthrax carcasses to water sources in the vicinity. After feeding, vultures visit watering points, where they drink, bathe, defaecate, and potentially regurgitate ingested material in and around watering points.80, 153, 270 Spores of B. anthracis occur in the faeces of white-backed vultures (Gyps africana) for up to two weeks after they have fed on contaminated carcasses in which bacteria have sporulated.80 Vultures may transport spores to watering points, but these concentrations may be insufficient for future transmission. A study of spore concentrations at watering points in Etosha National Park found that concentrations were low enough that animals are highly unlikely to be exposed to B. anthracis by drinking at these water sources. Vulture roosts have also been considered a possible area where spores could accumulate in the soil under the roosts from vulture guano. However, the vulture guano makes the soils under vulture roosts more acidic, reducing spore survival.116 Reduced spore survival in vulture guano and the relatively low number of spores transported on or in vultures may likewise reduce the potential for long-distance pathogen dispersal by vultures.
Other bird species, especially those attracted by insect activity at carcasses, may also be incidental carriers of the organism. Bacillus anthracis has been isolated from the crops of house sparrows (Passer domesticus).300 Transmission to susceptible hosts is not likely to happen, and birds such as the sparrow are considered unimportant in the epidemiology of anthrax.
Bacillus anthracis may be transmitted mechanically by vectors, such as house flies (Musca domestica) and other arthropods including biting flies, mosquitoes and ticks.135, 136, 138, 199, 241 Henning150 was the first to incriminate horse flies (Tabanidae) as mechanical vectors of anthrax to horses in South Africa. This observation was later corroborated by Kehoe.169 Although it has been suggested that biting insects smaller than the tabanids generally pick up too few organisms from a sick animal consistently to transmit the disease,136, 138 transmission by stable flies (Stomoxys calcitrans) and mosquitoes (Aedes aegypti and Aedes taeniorrhynchus) has been reported.188, 189, 198, 199, 346 The cumulative effects of a large number of bites and numerous interrupted feedings probably favour transmission. Tabanids appear to transmit B. anthracis more consistently.76, 195, 196, 198, 246, 256, 296 In Russia and Java, this method of transmission appears to be important as tabanids have been held responsible for transmitting the infection in 80 per cent of cases in horses and cattle.195, 262, 264 With the exception of transmission to horses, biting flies are not considered to be of great significance in the spread of anthrax in South Africa149 and the USA.369
Non-biting flies can act as carriers and transmitters of B. anthracis spores132, 216, 296 but, except under certain circumstances, they generally do not play an important role in the epidemiology of the disease. Such circumstances are found in the Kruger National Park, where blowflies (mainly Chrysomya albiceps and Chrysomya marginalis) provide a link between a carcass and its environment and play an important role in the transmission chain of anthrax, particularly to browsing animals, such as kudu (Tragelaphus strepsiceros).80 Blowflies feed on the body fluids from opened and unopened carcasses and, when replete or disturbed, fly off and land on vegetation, mostly leaves, in the close vicinity of the carcass, on which they deposit vomit and faecal droplets which teem with bacilli. (Figures 10 a and b and 11). Contamination of the vegetation in the vicinity of a carcass is in direct proportion to its distance from the carcass.34 Blowflies may disperse as far as 63,5 km from a carcass at a dispersal rate of up to 2,35 km per day.35 Droplets are usually deposited on the twigs or leaves of nearby bushes or trees, at a height of 1 to 3 m above the ground, which coincides with the preferred feeding height of kudu, thus accounting for the high vulnerability rating of this species in the Kruger National Park.34, 80 After a contaminated blood meal containing B. anthracis spores, blowflies may be life-long carriers, but vegetative cells disappear from their digestive tract within two weeks.84 It is worth nothing that the number of B. anthracis spores transported by blowflies, and how these may contribute to infections, has yet to be quantified.
Ticks collected from terminally ill animals have been found to contain B. anthracis,1, 46, 84, 334 but they do not seem to play a significant role in the transmission of the disease as inter-host transference of adult ticks is rare.
Most tropical and subtropical countries have a peak of infection during dry summer seasons and a low point six months after the peak.239, 368, 369 This also applies to South Africa, judging by the monthly figures for anthrax outbreaks during the mid-1920s, when anthrax was at its peak in South Africa.371
Anthrax is a seasonal disease, although the season in which outbreaks occur varies among systems. Rainfall and temperature have long been linked to anthrax outbreaks, with cases appearing after extremes in rainfall or drought, and under conditions of wet or dry seasons.23, 54, 80-82, 139, 245, 249, 298, 301, 362, 373 Even within systems, outbreaks can vary in their seasonality among species, for example in Etosha National Park wet season outbreaks are most common in grazing herbivores and dry season outbreaks in elephants,352, 362 or, conversely, in the Serengeti National Park, where outbreaks in grazers are more common after droughts, and outbreaks in browsers more common after heavy rains.139
The different seasonal risk factors observed in particular systems have given rise to numerous hypotheses for the role of the environment in the initiation of anthrax outbreaks. For outbreaks to occur under wet-season conditions, the hypotheses include rain moving spores around within the soil (unearthing spores), or moving spores onto vegetation; animals grazing on new grass growth near the soil surface; shifts in host diet in response to seasonal forage availability; increased rates of parasitism during wet seasons reducing host immune defenses against bacterial infections; and rainfall supporting the breeding of potential arthropod vectors.19, 53, 59, 144, 154, 362, 364
For outbreaks to occur under dry-season or drought conditions, hypothesized causes include: reduced forage or water availability concentrating herbivores and causing increases in animal density in certain areas; herbivores feeding closer to the soil on dwindling or wilted vegetation; herbivores consuming dry or prickly vegetation that causes micro-lesions in the mouth or gastrointestinal tract of herbivores, increasing the likelihood that ingested spores cross the epithelium barrier; declining water availability concentrating spores in low-lying areas utilized by herbivores for water, forage and mud or dust bathing; increased temperatures causing an increase in dust bathing activities with a risk of inhalational anthrax; and seasonal declines in host resistance due to poorer nutrition, increased competition for sparse resources, and heat stress.10, 80, 96, 114, 157, 369 Depending on the host species and its reproductive cycle, increased stress related to access to mates, gestation, or lactation can occur in either season.58 Animal movement patterns can also alter seasonal risk factors, if animal home ranges coincide with endemic anthrax areas more in one season or another.247, 399
Disentangling which of these many hypotheses may be relevant to a particular outbreak locality requires knowledge of the local environment and climate, and the ecology of the affected host species.
In wildlife under free-ranging conditions, the general rule is an endemic anthrax situation interspersed with periodic epidemics.80, 86, 100, 115, 213, 215, 270, 353 In the Kruger National Park, these cyclic patterns of outbreaks occur approximately in ten-year intervals, or multiples thereof, and are related to fluctuations in densities and concentrations of susceptible hosts.80, 86
The interdependency between the length of the survival period of B. anthracis and the environment in which it is present gave rise to the hypothesis that B. anthracis behaves as a saprophyte during its abiotic phase, and that it multiplies in ‘incubator areas’ outside the animal body.191, 369 The basis of this ‘incubator area’ or ‘soil capability’ hypothesis of Van Ness369 is that B. anthracis survives in soil in a dynamic state in which it undergoes cycles of germination and sporulation, dependent on fluctuating conditions in the micro-environment. In support of this abiotic life-stage, tantalizing laboratory studies have demonstrated that the pathogen can germinate, and perhaps multiply, in conditions of sufficient nutrients and moisture, such as found in the plant rhizosphere, earthworm guts, or soil amoeba.89, 288, 293 Germination of some spores in response to these cues could be the mechanism of decay in spore counts, if spores germinate but the vegetative cells die before sporulating.344 More recent studies describe fascinating interactions between B. anthracis and phages or other microbes in the environment, and the ability for vegetative cells to form biofilms.293, 294 It remains to be seen whether these interactions will be found to be important in the epidemiology of anthrax.
The biggest critique of this environmental multiplication hypothesis comes from the inability to detect a rise in spore numbers in the environment, only decay over time. During a long-term survey of soil samples from an endemic anthrax area in the Kruger National Park no evidence of growth or multiplication of B. anthracis within the soil under natural conditions could be found.80 However, an exception to this was when a slight increase in spore counts associated with grass roots at anthrax carcass sites, were found two years after an anthrax death in Etosha National Park362 where spore counts in all other sample types decayed over time. However, the mechanism behind this unusual pattern is not yet known, whether this truly represents multiplication in the environment, or clustering of spores in these areas due to soil-water dynamics. Bacillus anthracis is thought to be a poor competitor with soil microbes, especially those that synthesize antibiotic substances, and therefore cannot behave as a true saprophyte in nature. It has been found that, under suitable conditions of moisture and temperature, B. anthracis can be grown artificially in a laboratory in sterilized, but not in unsterilized soil.80, 240, 370 In addition, anthrax bacilli disappear from soils in the presence of certain plants, probably because of bactericidal/bacteriostatic properties of substances produced by the root systems.398 A recent genome study lends support to the idea that B. anthracis is an exclusively pathogen , based on features of the pathogen’s genome.286
The susceptibility of different animal species to anthrax varies considerably, and most warm-blooded vertebrate species have been infected, naturally or artificially, at one time or another.329 Herbivores are the most susceptible, and the disease occurs most commonly in cattle, sheep, goats, horses, donkeys and wild herbivores. Pigs, carnivores and ostriches are less susceptible, although outbreaks in these species do occur. Cold-blooded animals may have to be warmed, and birds cooled to render them susceptible to the disease.314 The susceptibility of animals to natural B. anthracis infection does not necessarily correspond with their susceptibility to experimental infection.329 Experimentally, cattle, horses and donkeys appear to possess a far greater degree of natural resistance than do sheep and goats, but this is not readily apparent under field conditions.149, 375 Discrepancies between susceptibility and prevalence of disease can also be explained in terms of differences in behaviour, such as feeding habits, and routes of infection. To illustrate this it has been found that in the Kruger National Park, the browsers have a higher vulnerability to anthrax than the grazers.80 This is explained by blowfly contamination of the nearby vegetation. In phosphorus-deficient areas in South Africa, osteophagia (Figure 12) may increase the likelihood of cattle contracting anthrax; while sheep do not usually manifest osteophagia under the same circumstances.60
In contrast to herbivores, pigs and carnivores are highly resistant to anthrax and the ingestion of large numbers of B. anthracis in infected meat is generally required to induce infection in them. The feeding behaviour of these animals, however, exposes them to much higher levels of infection than is the case with herbivores, and severe mortalities have been recorded in them under natural conditions such as conservancies.68, 80, 160, 164, 214, 222, 270, 279 On the other hand, anthrax outbreaks in carnivores in zoological gardens, and on fur farms most often occur when they are fed meat from carcasses which have not been adequately inspected.
Although the mortality rate is high and few animals which contract anthrax recover spontaneously,355 evidence of a “carrier state” has been reported in isolated cases. Dormant spores of B. anthracis were found to circulate in the blood of ‘black rats’ (Rattus norvegicus NIH black) for 30 days.375 Viable, virulent B. anthracis has been isolated from the lymph nodes of several apparently normal, fully susceptible impala (Aepyceros melampus) slaughtered four weeks after experimental infection with anthrax80 and from the ‘abdominal’ lymph nodes of apparently healthy cattle from an endemic anthrax area in Tchad.277 In addition, it has been reported that a carrier state may develop in pigs that have recovered from the disease.110 Although it is not clear what role such a carrier state plays in the epidemiology of anthrax, it is postulated that such carrier animals in an endemic anthrax area, being subjected to low-grade infection over a period of time, could develop a mild form of anthrax which, when they are subjected to severe environmental stress, could convert into peracute disease.115 It has also been shown experimentally that inhaled spores may lie dormant in the lungs.11, 285, 392 Clearance by the alveolar macrophages is slow and the spores may remain in the lungs for several weeks before the manifestation of signs of overt infection.113, 145
Age also affects the susceptibility of animals to anthrax; adults being generally more vulnerable than the young or subadults.43, 80, 82 Different behaviour patterns and feeding habits may predispose to this phenomenon, although there may also be specific, but as yet, not understood, physiological basis.
Humans have a significant influence on the epidemiology of anthrax. The introduction of animals into endemic anthrax areas, overpopulation of livestock within such areas, dissemination of infective material over long distances, and placing of undue pressure on drainage systems and rivers (creating stagnant situations) all tend to increase the incidence of the disease. In addition, poor socio-economic conditions seem to be one of the principle determinants of the occurrence of anthrax in domestic stock and humans.75, 77, 202, 232
Human infection generally occurs after direct contact with tissues of diseased animals or their products. In South Africa, cases of anthrax have been traced to the use of raw hide thongs made from infected hides and shaving brushes, blankets and cardigan jackets made from infected hair or wool. In Europe, many outbreaks of anthrax have been traced to infected, imported raw animal products. Hides from carcasses infected with B. anthracis may contaminate articles with which they come into contact. Even final products made after the curing or tanning of raw hides are not necessarily free from spores.149
Farm labourers, butchers, workers in tanneries and handlers of wool, hides and hair are most commonly affected. Infection is usually percutaneous (cutaneous anthrax). The 1979 to 1980 anthrax epidemic in Zimbabwe resulted in 9 445 human cases of which 141 (1,5 per cent) were fatal. Approximately 95 per cent of the cases were uncomplicated cutaneous infections. The clinical form of anthrax was not recorded in all fatal cases; of the 58 that were recorded, nine were intestinal anthrax, seven oropharyngeal, eight respiratory, 34 septicaemia following cutaneous infection, and four respiratory obstructions by oedema.51, 75, 77, 360 It was speculated that transmission of the disease by contact with infected meat and biting flies, particularly horse flies, played equally important roles in the epidemic in humans.360 Pulmonary anthrax, also known as “woolsorter’s disease”, occurs in humans who work in factories where wool and hair are handled, and results from the inhalation of dust containing spores of B. anthracis.
In developed countries food is rarely a source of infection in humans. However, in some developing countries where socio-economic conditions are poor and anthrax is endemic, human pharyngeo-gastro-intestinal anthrax occurs periodically among those who eat the meat of animals that have died suddenly, regarding the value of the meat as out-weighing the risks of contracting disease.5, 90, 91, 254, 366
Paradoxically, the infectivity of anthrax spores for humans is normally regarded as low.378 It has been found that in the dustiest parts of an industrial plant processing goat hair, the workers were inhaling between 600 and 1 300 anthrax spores during a working day without suffering any ill effect.72 The low infectivity of anthrax spores for humans is further borne out by recovering B. anthracis from the upper respiratory tracts of 14 out of 101 healthy, unvaccinated workers at two goat-hair mills.50 In addition, in the Kruger National Park, during three major anthrax epidemics in wildlife, many (more than 50) necropsies were performed and large teams of workmen were used to track down and incinerate carcasses; sometimes even cutting up and burning carcasses but none contracted anthrax.84, 270 Similar situations have been experienced in other wildlife parks.
Pathogenesis
Natural infection of animals is usually acquired by the ingestion of spores which germinate and gain entrance to the animal’s tissues, either in the pharynx or lower down the gastrointestinal tract. Infection may also occur through abraded skin or other cutaneous lesions and by insect bites. Infection via the respiratory tract,126 by inhalation of spores while grazing in dry, dusty contaminated sites, is possible, but considered rare.80, 397
Experimentally, animal species vary in their susceptibility to infection by different routes of administration of the organism. Infection is established most readily through the intramuscular route. The oral route is a less successful way of inducing the disease,315 and it generally requires a large number of organisms to produce a fatal infection.80, 121, 362 Cattle have been reported to be easily infected orally while being relatively resistant to subcutaneous infection.162, 291 It was also found that a subcutaneous dose of 36 B. anthracis spores is enough to establish a lethal infection in goats with and incubation period of two to three days.253 The oral LD50 for impala is in the order of 15 million spores as compared with 100 spores by the intramuscular route.84
The outcome of infection is influenced both by the host and the strain of B. anthracis.105, 161, 180, 212, 218, 350, 359, 377, 383 As animal species differ greatly not only in their resistance to lethal infection, but also in their susceptibility to the effects of the lethal toxin, the resistance to infection and intoxication appears to be based on separate mechanisms. Innate resistance appears to be dependent on the inhibition of the initial germination and/or multiplication of the bacteria.104, 180, 212, 383 On this basis it has been suggested that host species can be grouped into two categories.212
- Species resistant to infection e.g. rat (NIH black and Fischer strains), dog and pig but once the infection is established, are highly susceptible to the effects of the toxin. These species develop a low terminal bacteraemia (i.e. septicaemia).
- Species that are easily infected but resistant to the effects of the toxin (e.g. chimpanzee, guinea pig, rabbit, mouse, rhesus monkey, goat, sheep, horse, and cattle). Most of these species show a high terminal bacteraemia (i.e. septicaemia).
As reflected by the terminal blood picture, mice and guinea pigs are the most susceptible of the laboratory animals. Rabbits are more refractory than guinea pigs, whilst rats are very, but not totally, resistant. At death in many large animal species, B. anthracis bacilli are usually present in large numbers (± 107 to 108 /ml). There are species, e.g. pigs and carnivores, which usually have low numbers (104 bacilli/ml) of B. anthracis bacilli in the blood at death.218 Species differences in terminal blood counts are also found in wild animals. Species from the Kruger National Park, such as the greater kudu (Tragelaphus strepsiceros), nyala (Tragelaphus angasi), waterbuck (Kobus ellipsiprymnus) and roan antelope (Hippotragus equinus) consistently show a high terminal septicaemia, whilst in African buffalo and carnivores a wide variation, from virtually no organisms to numerous, occur.44, 230 These observations correspond well with vulnerability ratings of wild animals for anthrax during outbreaks in the Kruger National Park. Animals with high terminal blood counts have been found to be highly vulnerable to anthrax and vice versa.80 In humans, bacteraemia/septicaemia may occur, but the number of organisms is seldom as great as in some of the more susceptible animal species.103
The pathogenesis of anthrax has mostly been studied in laboratory animals.111, 125, 126, 166, 176, 211, 285, 305, 383-386, 388 Following subcutaneous injection, it was found that spores soon germinate to form actively dividing encapsulated vegetative cells which produce toxin. Within about two hours of inoculation, oedema begins to develop at the site. The oedema develops progressively as further bacterial multiplication takes place. The bacteria are usually confined to the initial site of infection and are usually not present in the extensive oedema fluid surrounding the primary lesion.69 Anthrax bacilli are later transported from the primary site via lymphatics to regional lymph nodes where further multiplication takes place and whence vegetative bacilli continuously enter the blood stream. Initially, the bacteria are filtered out by the reticuloendothelial system, particularly in the spleen, until this system is overwhelmed.126, 166, 176 During the final 10 to 14 hours of the host’s life, the bacteraemia increases progressively (at a doubling rate of 50 minutes in mice, guinea pigs and rhesus monkeys, 95 minutes in sheep, 125 minutes in rats and 150 minutes in chimpanzees) to reach a fairly constant terminal level of about 104 in Fischer rats, 106 in NIH black rats, 107 in mice, and 108 bacteria/ml in sheep.166, 175, 181, 212, 351, 377, 383
The variation in the severity and extent of lesions that develop is dependent on the virulence of the organisms, the susceptibility of the animal, the infective dose, and the route and site of infection.149, 159, 329 At the site of the invading organisms, highly susceptible hosts (e.g. most herbivores) show an initial mild inflammatory response followed by bacteraemia with necrosis and haemorrhage involving tissues and many organs, whilst resistant hosts (e.g. carnivores) reveal in most instances only a severe localized inflammatory response.125
Bacillus anthracis bacilli possess two primary virulence factors as already mentioned. The summative effect of the individual components of the toxin and of the capsule is to inhibit phagocytosis, increase capillary endothelial permeability and delay blood clotting. The PA, LF and EF proteins are well characterized and are produced simultaneously during the exponential phase of growth of the organism. The PA is an 83 kDa protein which binds to receptors on mammalian cells and is cleaved to a 63 kDa fragment forming a secondary binding site to which LF and EF compete to bind.237 The PA 63 complexed to LF or EF undergoes receptor mediated internalization and the LF or EF is translocated into the cytosol upon acidification of the resulting endosome PA 63 oligomerizes to form a heptamer/ prepore that forms a channel in the host cell membrane through which the LF and EF are translocated into the cytosol where the acidic pH enables the release of lethal toxin (LT) and oedema toxin (ET). The oedema factor is a calmodulin-dependent adenylate cyclase that catalyses the abnormal production of cyclic-AMP, inducing altered water and ion movements resulting in the characteristic oedema of anthrax.207 The role of the EF in the disease process may be to prevent mobilization and activation of polymorphonuclear leukocytes and thereby prevent the phagocytosis of the bacteria.206, 207 The oedema factor within the host protects bacteria from phagocytic destruction, and increases intracellular levels of cyclic AMP (cAMP) therefore resulting in a severe oedema and death. The lethal factor is a zinc-dependent metalloprotease184 that inhibits mitogen-activated protein kinase-kinase (MAPKKs).97, 98 there by disrupting cell cycle regulation and causing cell death in macrophages. The lethal toxin is responsible for the terminal shock in anthrax.140, 242, 243
Extreme hypoxia, hypoglycaemia and alkalosis may contribute to most of the clinical signs observed. Loss of body fluids into the tissues (oedema) and body cavities, such as the lungs, mediastinum, and peritoneal, pleural, and pericardial cavities, causes haemoconcentration in diseased animals.104, 307 Respiratory distress and severe hypoxia in animals in extremis are caused by pulmonary oedema,307 and utilization of available oxygen by the massive numbers of circulating bacilli104 and/or depression of the central nervous system.32, 182, 376 Hypoglycaemia, decreased levels of serum calcium, and increased levels of serum potassium and chlorine are recorded during the terminal stages of the disease.29, 376 In some host species, leukocyte counts and haematocrit increase concurrently with the changes in calcium.376 The neuromuscular irritability and convulsions exhibited by some animals in the terminal stages of anthrax are probably the consequence of decreased serum calcium and increased potassium. Extreme hypoxia and hypoglycaemia prevent the development of convulsions.376
Clinical signs
The incubation period of anthrax under natural conditions is not known, but probably ranges from 1 to 14 days.28, 322 Under experimental conditions, it varies considerably, and is influenced by the virulence of the organisms, the resistance of the animal, the route of infection and the number of infecting organisms.124, 145
Most animals suffering from anthrax develop a fever but its severity is extremely variable.2, 127, 251, 258, 306, 329, 374 It appears to be characteristic for a species, and may depend on the number of infecting organisms.374 After being infected subcutaneously, pyrexia is usually observed within one to two days.149 The fever usually declines before death.253 In goats anthrax bacilli were observed in blood one hour before death.253
Three different manifestations of anthrax are recognized: peracute or apoplectic, acute, and subacute to chronic forms. Cattle, sheep, goats and some wild ruminants, such as kudu, roan antelope and impala, mainly manifest the peracute and acute forms. Horses, donkeys and zebra suffer from the acute form. (Figures 13 a and b) Omnivores (e.g. pigs), carnivores and immunized animals (i.e. immunized animals challenged with high doses of infective material, or animals with lowgrade immunity) usually contract the subacute to chronic form.
In peracute anthrax, the course of the clinical disease is usually less than two hours. The majority of animals are found dead without having shown signs of illness. In those in which clinical signs occur, pyrexia (depending on the species), restlessness or anxiety, muscle tremors, dyspnoea, congestion of mucous membranes, ruminal stasis, collapse, and terminal convulsions may be observed. Blood-stained fluid sometimes exudes from the nostrils, mouth and anus. Experimentally, impala and most wild ruminant species under natural conditions rarely show clinical signs until immediately before death when they are afebrile and manifest pronounced dyspnoea due to lung oedema, convulsions, and paddling movements of the legs. Terminally, they usually show opisthotonus with the forelegs rigidly extended. Similar clinical signs are regularly seen in wild ruminants naturally dying of the disease (Figure 14).84, 230
The course of acute anthrax is usually less than 72 hours. A rise in body temperature is an inconsistent feature. At first, affected animals remain standing with their heads hanging and their eyes staring; they are depressed, lag behind the others, walk about listlessly, and lie down frequently. Respiration is laboured and rapid, and scattered small haemorrhages may occur in the visible mucous membranes and skin (Figure 15). The appetite is lost, rumination is suppressed and acute digestive disturbances may set in. Some animals may develop diarrhoea, which is usually haemorrhagic.230 In lactating cows, milk production decreases and the small amount of milk still secreted is either blood-stained or yellow. Pregnant animals may abort. Oedema of the tongue and subcutaneous oedematous swellings in the region of the throat and ventral parts of the thorax, abdomen and perineum may occur. Horses may develop oedematous foci or more generalized subcutaneous swelling of the ventral parts of the body and perineum, usually at the sites where the infection due to the bites of stable or horse flies took place. Horses that become infected orally, develop enteritis, colic, a high fever, and depression. They generally die within two to four days of infection or appearance of the first clinical signs.
In the subacute to chronic form of the disease, the course usually extends for more than three days before recovery or death occurs. The most frequent sign is an oedematous swelling of the face, throat and neck following primary infection of the pharynx, pharyngeal tissues and regional lymph nodes (Figure 16). The swelling in the pharyngeal region may become so extensive that it interferes with respiration (and may result in asphyxia) and the ingestion of food and water. The infection may progress to a more acute stage, or it may remain localized for some time, or the animal may recover. Recovery has been witnessed in carnivores and pigs, which have some degree of natural resistance to anthrax.41, 110, 355, 375
Serological evidence indicates that highly susceptible herbivores do suffer subclinical anthrax infections.8, 57, 117, 204, 255, 355 In serological surveys on wildlife in the Etosha National Park in Namibia, where anthrax is endemic, it was found that naturally acquired anthrax antibodies are common with high titres in jackals and common to rare, with low titres, in herbivores.16, 57, 355 This is thought to reflect both differences in the amount of pathogen exposure, and differences between herbivores and carnivores in disease resistance. Serology has been recommended as a form of disease surveillance, by tracking disease exposure in sentinel species.8, 9
In humans, anthrax manifests in one of three clinical forms (cutaneous, pulmonary or intestinal). Meningitis and septicaemia may develop during the course of any one of these.36, 75, 77, 189, 313, 366 The cutaneous form accounts for more than 95 per cent of reported cases in humans.36, 189, 278, 313 There is no evidence that B. anthracis can penetrate the intact skin, the infection usually entering the body through abraded skin or by means of an insect bite. The most prevalent sites of cutaneous anthrax are the exposed areas of the body, such as the head, face, neck, arms, hands and legs.
Cutaneous lesions in humans are characterized by the development of a papule surrounded by a zone of hyperaemia and oedema of adjoining tissues.278 Central necrosis of the lesion occurs with the formation of an eschar, and is followed by ulceration. The cutaneous lesion is generally not painful, and, despite the designation ‘malignant pustule’, there is an absence of pus and suppuration at all stages.360 The subsequent course depends greatly on the site of the lesion. In approximately 90 per cent of cases, cutaneous lesions regress and spontaneous recovery occurs, but in about 10 per cent of cases the infection spreads to the regional lymph nodes and develops into a fatal septicaemia. Pulmonary anthrax (woolsorter’s disease or mediastinal anthrax) occurs when dust particles laden with anthrax spores are inhaled and deposited in the alveoli where they are phagocytosed by macrophages and transported to the regional lymph nodes in which they vegetate and the bacilli multiply. From there bacteria may enter the blood and initiate a rapidly fatal septicaemia.285 This form usually manifests as an acute atypical pneumonia or influenza followed by signs of cardiac failure.2, 37, 38, 285, 397 Virtually all untreated cases are fatal.
Intestinal anthrax in humans is caused by eating uncooked or underdone B. anthracis-infected meat. Although this route of infection is considered most unlikely in developed countries,37, 366 it is not uncommon in developing countries.75, 77, 278 Organisms penetrate the mucosa and form lesions similar to the cutaneous eschar, most commonly in the wall of the terminal ileum or caecum; but the oropharynx, stomach and other parts of the intestines are occasionally affected. The nature of the clinical signs depends on where the lesion is located. Involvement of the oropharynx results in fever, necrotic pseudomembranous mucosal lesions, cervical lymphadenopathy and marked oedema of the surrounding tissues extending some distance from the lesion. The neck and pharyngeal regions may be markedly swollen. Involvement of the intestines causes nausea, vomiting, anorexia, fever, abdominal pain and a haemorrhagic enteritis.75, 77, 303, 366
Pathology
The principal lesions in septicaemic anthrax in animals comprise oedema, haemorrhage and necrosis.125, 197 Depending on the route of infection, host susceptibility and virulence of the bacteria, the nature and extent of the lesions vary at necropsy. Thus, in some carcasses, only lesions consistent with septicaemia are evident, while in others localized necrotizing lesions are found. Rarely, only enlarged lymph nodes are encountered at meat inspection.41, 110, 277, 321
Septicaemia and bacteraemia are generally consistent features of anthrax, although the numbers of bacilli encountered in the blood may vary considerably, depending on the species.44
In ruminants, in which the course of the disease is usually acute or peracute, the most consistent changes encountered during a necropsy include evidence of rapid post-mortem decomposition of the carcass (resulting in marked bloating soon after death); incomplete development of rigor mortis; oozing of blood or blood-stained fluid from the natural body openings such as the nose, mouth and anus; dark-red, poorly-clotted blood; petechiae and ecchymoses throughout the carcass (Figures 15 and 17); degenerative changes in parenchymatous organs; extensive pulmonary oedema; excessive amounts of blood-tinged serous fluids in the peritoneal, pleural and pericardial cavities; oedema and haemorrhage in individual lymph nodes; and an enlarged pulpy spleen, the red pulp being blackish-red, soft and sometimes semifluid. As suggested by the names ‘splenic disease’ and the Afrikaans version ‘miltsiekte’, severe splenomegaly (Figure 18) is considered by many to be the most characteristic change at necropsy, but it is not a consistent feature and its absence does not rule out the possibility of anthrax. Certain species such as sheep,125 horses, pigs and impala84 rarely develop splenomegaly.
Other less frequent macroscopic lesions include localized inflammation and haemorrhages in the mucosa of the gastrointestinal tract (Figure 19), particularly in or in close proximity to lymphoid follicles and Peyer’s patches, and free blood in the colon; drops of blood exuding through the skin; localized oedema in the subcutaneous tissue, wall of the gastrointestinal tract and around lymph nodes; haematuria;388 and congestion of subcutaneous blood vessels imparting a ‘fiery’ appearance to the carcass.80 Most wild ruminants that have died from anthrax manifest a vasogenic brain oedema and the presence in the larger blood vessels of poorly formed and disintegrating post-mortal blood clots, containing numerous encapsulated bacteria.197
Pigs may suffer from septicaemic, pharyngeal or intestinal forms of the disease. At one time the pharyngeal form was the most common110 but, with changing regulations regarding the feeding of food waste to pigs, this has become rare.279 In those that have died from the subacute to chronic disease resulting from primary invasion of B. anthracis through the mucous membrane of the pharynx, the cause of death may be the result of asphyxia149 following severe oedematous swellings of the mucosa and submucosa of the pharynx and glottis, and of the peripharyngeal and subcutaneous connective tissues of the throat and neck regions. A diphtheric to necrotic pharyngitis and tonsillitis,74, 149 or eschar development at the site of entry of the organisms, may be apparent while the regional lymph nodes are enlarged to several times their normal size and are bright to dark-red110 due to severe lymphadenopathy resulting from oedema, hyperaemia, haemorrhage and necrosis.
In more chronic cases, lesions resembling tuberculous granulomas may occur in affected lymph nodes.41, 290 Evidence of septicaemia is often absent from such cases. In those animals in which primary infection has occurred lower down the gastrointestinal tract, localized lesions may be present at the site of entry of the organism. These consist of focal or multifocal regions of intense, acute, haemorrhagic inflammation with oedematous swelling of the wall of the intestine and associated mesentery, and regional lymphadenopathy. Mucosal ulceration may occur.149 The capsulated bacilli which may be difficult to detect in blood smears are present in relatively large numbers (± 105 cfu/ml) in the oedematous mesenteric fluid.280
Horses, donkeys and zebra usually suffer from septicaemic anthrax.80, 110, 270, 329 With insect transmission, horses also manifest localized swellings at the sites of the insect bites, usually on the lower parts of the thorax and abdomen, shoulders, legs, perineum and around the external genitalia, with, in the latter stages of the disease, the development of the septicaemic form.149, 324, 329
Severe inflammatory oedema of the soft tissues of the head, tongue and throat, stomach and intestines are characteristic features of anthrax in carnivores.55, 197, 388 In the African lion, localized lesions with no or late onset of septicaemia are often seen.197 These lesions are of variable severity, but are usually outspoken and localized in the tissues of the face, oral cavity and the regional lymph nodes. The changes are invariably characterized by localized necrotic glossitis or stomatitis to locally extensive necrotic cellulitis of the lips and the face, accompanied by severe oedema causing severe swelling of the tissues of the head.
Diagnosis
The guidelines for the surveillance and control of anthrax issued by the World Health Organization comprehensively cover diagnostic techniques.391
The history, including clinical manifestations and necropsy findings (if, mistakenly, the carcass has been opened), is usually the first step in the diagnosis of anthrax, and should lead to further confirmatory procedures.
Blood or tissue smears should be made in an attempt to confirm the diagnosis of anthrax. In relatively fresh carcasses a minute quantity of blood can be extracted with a 1 ml syringe from any available vein to make the smears (the blood in animals dying from anthrax is non-clotting or clots poorly). Otherwise, the smear can be made from blood which is already accessible or from a small puncture wound, incision or clipping of the skin of the lip, ear or, preferably, coronet of a hoof. Smears should be appropriately stained (see Aetiology) and examined microscopically. Bacillus anthracis bacilli are readily detected in smears stained by a method to demonstrate their capsules. A diagnosis may also be made by preparing smears from the oedematous fluid that surrounds localized lesions or from lymph nodes regional to such lesions, such as those that occur in the region of the mesentery, throat and neck of pigs47, 280 and African lions197 that have died from anthrax.
Presence of typically stained bacilli is treated as pathognomonic for anthrax. Their absence, however, does not necessarily exclude the possibility of anthrax. As indicated in the section on Pathogenesis, a variation in their number in a smear can be expected not only within animal species, but also between species; some of which consistently show high terminal bacteraemic counts, while in others few or no B. anthracis organisms can be detected terminally. In live animals during the early stages of the disease, anthrax organisms are seldom present in sufficient numbers to be demonstrable in blood smears. Low numbers can also be expected in animals which have been treated with antibiotics or in those possessing some immunity. It must further be borne in mind that, as soon as an animal dies, the anthrax Bacillus in an unopened carcass undergoes changes in its morphology. The capsule commences to disintegrate and the protoplasm to degenerate, taking the stain more and more faintly until only ghost-like bacilli are seen, the so-called ghost cells or “shadons”. The capsular material is the last to disappear.74
In order to prevent or minimize the contamination of the immediate surroundings of the carcass with B. anthracis spores, and also to avoid possible infection of the prosector, a necropsy should not be performed if the history and clinical signs indicate anthrax. Only under special circumstances, such as for research purposes, with suitable precautions and permission of the veterinary authority can a post-mortem examination on an animal be performed.. If mistakenly opened, post-mortem examination should be stopped immediately after the first suspected sign of anthrax has been noticed. For this reason histopathological examinations of organs or tissues as a diagnostic procedure are not often performed. Histologically, lesions are invariably associated with B. anthracis bacteria.197
If, after the examination of a blood smear, anthrax is still suspected but unconfirmed, suitable samples (blood, mesenteric fluid, other oedematous fluid or small tissue excisions) should be collected and submitted to a laboratory for bacteriological examination. The isolation and identification of B. anthracis from specimens originating from a relatively fresh carcass are not particularly difficult, while such attempts on material obtained from severely decomposed carcasses are often difficult or even unsuccessful.320, 388 Swabs of nasal or oral orifices should be suspended in 0,5 ml of sterile water which is then plated on selective PLET agar (see below) after heating for 15 minutes at 62 to 63 °C. Higher temperatures and longer treatments can reduce spore viability).356 Being furthest away from the gut, from where the major invasion of the body by putrefaction bacteria takes place, blood specimens obtained from the coronets of the hooves offer the best chance to detect the organism in smears or by isolation in older carcasses. In general, the preferred specimens for diagnostic purposes depend on the state of the carcass and the length of time that has elapsed between death and collection. Soil from the immediate vicinity of the carcass (preferably underneath) has also been used with great success for culturing purposes.215, 354
Bacillus anthracis grows readily on artificial media, and when isolation is attempted from uncontaminated fresh specimens, nutrient agar can be used, but best results are, in general, obtained on media containing serum or blood (preferably of horse origin). Care should be taken not to use blood or serum from animals that have been immunized against anthrax. In specimens from decomposed carcasses, from processed products of animals that have died of anthrax, or from the environment, e.g. soil, detection is complicated by a background flora of other bacteria, many of which will probably be other Bacillus spp., particularly, the closely related B. cereus. In such cases, it is necessary to use selective isolation techniques. A procedure for the selective isolation of B. anthracis is shown in Figure 20. The PLET medium of Knisely186 is generally recommended.49, 70, 84, 227, 228, 265 It consists of Difco Heart Infusion Agar as a basal medium with 30 IU/ml polymixin, 300 IU/ml lysozyme, 300 µg/ml disodium ethylenediamine tetra-acetate (EDTA), and 40 µg/ml thallous acetate. PLET medium is suitable for the isolation of B. anthracis spores from soil, and is sensitive to concentrations as low as three spores per gram.228
Seeded serum, blood or nutrient agar plates should be incubated for 12 to 24 hours, and PLET plates for up to 48 hours at 37 °C. Colonies suspected of being B. anthracis on the grounds of colonial morphology and tenacity (see Aetiology), are lifted with a bacteriological loop and seeded onto a blood agar plate.
An isolate with the characteristic colonial morphology and nature (matt appearance, fairly flat, white or grey-white, 2-4 mm in diameter, distinctly tacky and often having curly tailing at the edges), and which is non-haemolytic, or only weakly haemolytic, non-motile, sensitive to anthrax specific gamma-phage and penicillin, and able to produce a capsule in vitro in defibrinated blood or on bicarbonate media under a carbon dioxide atmosphere in vivo in laboratory animals or demonstration of virulence factors including capsule using molecular techniques, is considered as B. anthracis (Figure 16).347, 354 Capsule formation can be demonstrated by transferring a pin-head quantity of growth from a suspect colony to approximately 2,5 ml of sterile defibrinated blood, and incubating it at 37 °C for five hours or overnight. A smear is then made from the blood, which is stained with a capsule stain and examined microscopically. Capsule formation can also be induced by plating a suspect colony onto nutrient agar containing 0,7 per cent sodium bicarbonate and incubating it overnight at 37 °C in an atmosphere of 20 per cent carbon dioxide (generally a candle jar will suffice or use of anaerobic sachets).
For many years the isolation and confirmation of the identity of B. anthracis were done in laboratory animals. This is generally unnecessary and, in line with increasing aversion to the use of animals for scientific tests, this should strictly be the last resort.354 Conventional and real- time PCR assays detection of capsule on PXO2, as well as regions on chromosome PXO1 have been developed for B. anthracis347 with real- time PCR offering more specificity and sensitivity than conventional PCRs.
Bacillus anthracis is non-motile and any of the existing motility tests can be used. However, motility testing is not a primary test like capsule formation and testing for sensitivity to gamma-phage and penicillin. The ability of anthrax specific gamma-phage to induce lysis of B. anthracis bacilli is a phenomenon which is highly specific and is increasingly being used as a diagnostic aid in laboratories dealing with anthrax.45, 280 On rare occasions, however, a phage negative B. anthracis strain or a phage positive B. cereus strain is encountered.354 The phage test should therefore be used in combination with other tests. Penicillin sensitivity is tested by streaking a colony of the organism growing on solid medium, or one obtained from a suspension of a colony prepared in peptone water, on a suitable solid medium on a plate, and then applying discs containing penicillin G (two or ten units) to its surface.
Measuring serological response is mostly used in anthrax diagnosis,, , to monitor response to vaccines and for epidemiological studies in humans, livestock and wild mammals. (Kohler et al 2016)252, 347, 355 These are mostly based on antibodies to the toxin antigens, primarily the protective antigen component of the toxin (indirect ELISA)137, 252, 253, 274 and neutralization of antibodies (TNA, toxin neutralization assay)done, using commercial or purified toxin antigens.152 Although not difficult to perform, they are, at present, confined to a few laboratories capable of preparing the necessary purified toxin antigens which are not available commercially.354
The Ascoli test7 has been used for the detection of B. anthracis antigen in dried-out tissues of animals that have been dead for a long time. The test is not rigorously specific and is not suitable for detection of B. anthracis in environmental samples.354
Differential diagnosis
In general, all causes of sudden death and of haemorrhagic septicaemia in animals, especially when it occurs in a group context, may be confused with the peracute and acute forms of anthrax. Some of these are:
- Diseases caused by other infectious agents. The most obvious include the clostridial diseases (blackquarter, malignant oedema, bacillary haemoglobinuria and the enterotoxaemias) and peracute pasteurellosis in ruminants, African swine fever, classical swine fever, and oedema disease in pigs, and African horse sickness, purpura haemorrhagica and colitis in horses.
- Nutritional deficiency or poisoning. Sudden death can occur at pasture from bloat in ruminants or colic in horses, ‘gousiekte’ in ruminants caused by ingestion of certain plant species of the Rubiaceae family or poisoning with plants containing such substances as prussic acid, nitrite, fluoroacetate and cardiac glycocides. Inorganic and organic poisons which most often cause sudden death are arsenic, lead, copper, magnesium, urea, nitrate/nitrite and the organophosphorus compounds . A deficiency of vitamin E/selenium in pigs may lead to sudden death from mulberry heart disease.
- Sudden widespread deaths during environmentally stressful conditions such as lightning strike or electrocution, sudden severe drops in environmental temperature and severe droughts. The history usually reveals the cause.
- Acute snake bite poisoning. Extremely poisonous snakes exist in many parts of the world, but poisoning is rarely associated with more than a single animal on any one particular occasion.
- Trauma. Accidentally or intentionally (such as sadism) inflicted trauma causing internal haemorrhage or damage to the central nervous system can cause sudden death.
Localized oedematous lesions, such as those caused by snake bite, abscessation, purpura haemorrhagica and infectious diseases, e.g. backquarter and malignant oedema, could be confused with subacute to chronic anthrax where the infection has remained localized.
Control
Anthrax control measures are aimed at breaking the cycle of infection and consist basically of a surveillance system, prophylactic procedures (immunization, treatment and disinfection), and disease regulatory actions (quarantine, immunization, treatment, proper disposal of carcasses and disinfection). For obvious reasons these control measures are difficult to apply in free-ranging wildlife, and therefore a different set of rules applies to the control of anthrax in these animals. Being a notifiable disease by law in most countries, anthrax control procedures are usually prescribed and enforced by government veterinary services. For the general public, not under direct threat of anthrax, control of the disease is aimed mainly at controlling the disease in livestock.
Surveillance
Good surveillance procedures should provide a country with an indication of its high-risk anthrax areas. It is imperative that an early warning system is in place so that an outbreak can be identified at an early stage and combated before it can assume major epidemic proportions. There is also a responsibility to notify the rest of the country and world of any anthrax outbreak that occurs within its boundaries and is listed by the “Office International des Epizooties” (OIE) as a “notifiable animal disease.”261 All countries that are part of this international disease surveillance network are obliged to send records of anthrax outbreaks to the OIE. There are, however, reasons to believe that complacency has resulted in defective surveillance and reporting of the disease in many countries at all levels of development.156
This means that there is a higher prevalence of anthrax in virtually all countries of the world than OIE and other records indicate. Hugh-Jones156 is of the opinion that if this is to change, veterinary authorities must first regard anthrax more seriously and improve surveillance; the implementation of an effective disease control program will then achieve a true zero-prevalence, at least in livestock.
Immunization
Prophylactic methods to minimize the spread of B. anthracis in many countries are regulated by law. The large anthrax outbreaks which occurred in Zimbabwe during the late 1970’s serves as a vivid reminder of what can happen if vaccination of livestock is interrupted.75, 77, 138, 189, 278, 360
Most anthrax vaccines in use in the world at present utilize the toxigenic, non-capsulating (pXO1+/pXO2-) B. anthracis 34F2 isolated in 1937 by Sterne.326, 327 It is used essentially as originally formulated with approximately 107 spores/ml suspended in 1,5 per cent saponin in 50 per cent glycerol-saline.354 Saponin and glycerine are used to enhance the immunizing efficiency.326, 328 Uncapsulated B. anthracis variants may lose their immunogenicity on subculture.331 It is therefore important that standardized procedures for the manufacturing of anthrax vaccines be used, such as prescribed by the World Health Organization.390
The live spore Sterne vaccine is, for all practical purposes, nonpathogenic in most domestic animals.87, 88, 332, 333 It, however, appears to retain a degree of virulence for certain species, such as goats and llamas.51, 328 In such species, two inoculations one month apart, with the first being one-quarter of the standard dose and the second being the full standard dose, are recommended.354 These animals should be injected in the inner thigh or tailfold as these animals are inclined to show allergic reactions with swellings at the site of injection, which may cause suffocation if the inoculation is given in the neck.. In horses, being slow to react, two standard doses one month apart and a single annual booster thereafter are recommended.67 In the other species a single inoculation provides effective immunity for about a year,328 with annual revaccination being generally considered to be adequate to ensure permanent protection in most situations.332 Effective immunity generally develops within a week of vaccination, although in horses it may take a month or more.329 In an experiment Boer goats immunized with one or two doses of Sterne 34F2 live spore vaccine and challenged with fully virulent B. anthracis spores were accessed. Of the goat groups vaccinated once (vaccinated once and challenge four weeks later) 60 per cent survived and 80 per cent (vaccinated once and challenged a year later) survived, while those vaccinated twice survived the challenge.253 The sera of the latter group of Boer goats and naive goats were used to investigate a passive mouse protection model.268 This study found that the passive mouse protection model could potentially be used to evaluate the protective immune response in livestock animals vaccinated rather than using a virulent challenge in the target species.
Vaccine failures may occur as a result of poor quality or low potency vaccine, animals not receiving the correct dose, or an as yet unexplained poor immunogenic reaction of individuals.80, 354 Outbreaks of anthrax in livestock are usually brought under control within a week to ten days of vaccination of affected herds.
In China and in the countries of the former USSR, live spore vaccines are prepared for use in humans.299, 354 In most other countries, live spore vaccines are not licensed for use in humans. In the UK and USA, non-living human vaccines developed in the 1950s and 1960s, respectively, are produced principally for military use. The UK vaccine is an alum-precipitated cell-free culture filtrate of the Sterne strain, while the USA vaccine is an aluminium hydroxide adsorbed cell-free culture filtrate of a non-capsulating, nonproteolytic derivative of bovine isolate V770.354
Human vaccination is only recommended for persons in at-risk occupations, particularly those in industries concerned with handling of animals or processing of animal products from anthrax endemic regions. The duration of protection afforded in humans by vaccination is uncertain and, on empirical grounds, annual boosters are recommended for workers in at-risk occupations. In certain circumstances, post-exposure vaccination at the same time as administration of antibiotics may be appropriate. Vaccines for use in humans are not freely available.
Treatment
In domestic animals treatment is indicated in all clinical cases. Even in advanced cases which may terminate in death; the rationale being that treatment will greatly reduce, if not entirely eliminate, the infecting load of anthrax bacilli, thereby reducing possible subsequent contamination of the environment.
In particularly valuable animals which have been exposed to anthrax, treatment with antibiotics can be used as a prophylactic measure.119, 250 This was performed successfully in the Kruger National Park when anthrax broke out among roan antelope in an enclosed camp.84
Hyperimmune serum has been used in the past for treating anthrax cases,329 but has been abandoned in many countries in favour of antibiotics, although it is apparently still in use in China94 and Russia.354 It is of negligible value in veterinary medicine, but if used correctly, it might still be life-saving in certain human cases which do not respond to antibiotic therapy.354
All strains of B. anthracis appear to be sensitive to tetracycline, erythromycin and chloramphenicol, whilst most are sensitive to gentamycin, streptomycin and penicillin.209, 250, 259 Penicillin, dihydrostreptomycin and gentamycin have a bactericidal effect, while oxytetracycline, chlortetracycline and chloramphenicol have a bacteriostatic effect on most strains of B. anthracis.209, 250, 259 In advanced cases, antibiotic treatment delays, but does not prevent, death.145 In order to prevent the organisms from producing further toxins, antibiotics should be selected on the basis of their bactericidal effects. Penicillin and dihydrostreptomycin are therefore recommended in preference to the bacteriostatic antibiotics for the treatment of anthrax diseased animals.
Concurrent antibiotic treatment and vaccination with a live spore vaccine are clearly contraindicated.354, 380 The treatment will prevent the live vaccine from taking effect.354
Quarantine procedures
It is vitally important, once an outbreak has been identified, that any possible source of infection immediately be isolated in order to prevent further spread of the disease. The infected area (e.g. a farm or group of farms) and any surrounding farm or area which may potentially be infected should be delineated and all livestock movements in and out of the area stopped. Local government veterinary officials should have the authority to immediately enforce such quarantine procedures.81
All unaffected livestock within the quarantine area should be immunized and kept in isolation under the observation and supervision of a government veterinary official, or other authorized person, for at least two weeks after vaccination. Clinically affected and high-risk in-contact animals, or particularly valuable animals should first be treated (see above) and then immunized a minimum of three days after cessation of treatment. Such animals should be kept separate from the others.
Disposal of anthrax carcasses
The primary source of environmental contamination of anthrax spores is the carcass of an animal that died of anthrax. In order to reduce sporulation of the vegetative growth form of B. anthracis, and thus potential contamination, carcasses should not be opened. In most countries, the opening of carcasses is prohibited by law when anthrax is suspected. Such carcasses should be disposed of intact and the preferred methods of doing this are incineration, rendering (effective controlled heat treatment) or burial.
If carcasses are incinerated, the possibility should be kept in mind that viable spores of B. anthracis can escape with the smoke/steam above burning anthrax infected carcasses.151 Bacteria, predominantly Bacillus spp., have also been isolated from the base of the exhaust stack of a hospital incinerator.27 Incineration pyres should therefore be constructed in such a way that the fire rapidly takes hold and burns fiercely with as little smoke in the updraft as possible.151, 358 Down-directed blowtorches or portable incinerators are used for this in some countries.354
Rendering is essentially a cooking process in which carcasses or parts of them are sterilized. This is a sophisticated process requiring the necessary infrastructure and correct procedures being carried out during the collection, transport and treatment phases. Very few countries and areas are however equipped to do rendering.
Burial is not considered a long-term solution and can result in future anthrax outbreaks.354 Spores may be brought to the surface mainly by scavengers (animals and humans), cultivation, excavating for buildings and soil erosion. Burial should therefore be discouraged but, if there is no feasible alternative, the carcass should be buried at a depth of preferably two metres, after first being covered liberally with chloride of lime and covered completely, or preferably wrapped, in good quality plastic sheeting before the “grave” is filled in. Most B. anthracis organisms within an unopened carcass do not sporulate when oxygen levels fall below a critical level and are further inactivated by putrefactive processes and/or disinfection by chloride of lime. This method was used with great success during anthrax outbreaks in far-off rural areas in some developing countries.84 The contaminated area should also be fenced off and hazard signs posted.
If burial or incineration of the carcass is not possible at the time, the only remaining alternative is to leave the carcass on the spot and protect it adequately from scavengers, and particularly humans, by using the above chloride of lime method, but without burial. In this way the gas produced by chlorine virtually sterilizes the carcass and immediate surroundings and has the added advantage of keeping unwanted scavengers, including humans, out.354 Control measures practiced during anthrax outbreaks in livestock and wildlife in the Northern Cape Province in South Africa in 2007-2008 included vaccination of livestock; burning of the carcasses; treatment of the carcass sites by spraying either 10 per cent chlorine or 10 per cent formalin on the carcasses and covering them with black plastic or tarpaulins to increase bacterial vegetative cell death and limit blowfly and scavenger access to the carcass. These control measures reduced or possibly even eliminated the inoculum at the treated carcass sites as no spores could be isolated in 2012 from the same sites and bones.143
Disinfection148
The WHO has offered guidelines for the disinfection of B. anthracis-infected material.354, 389 The following are the most relevant:
Manure, dung, bedding and slurry
Anthrax-contaminated manure, dung and bedding should be incinerated or autoclaved (121 ± 1 °C core temperature for 30 minutes). Immersion in 10 per cent formalin is an alternative. Slurry from pigs or cattle should be disinfected with formaldehyde to a final concentration of two to four per cent and the mixture thoroughly stirred. This should be left for at least four days with occasional stirrings.
Surfaces
Disinfection of contaminated surfaces involves a three step approach:
- For preliminary disinfection use 30 per cent formalin or four per cent glutaraldehyde in amounts of 1 to 1,5 litre/m2 for two hours.
- Cleaning by straightforward washing and scrubbing using ample hot water.
- For final disinfection apply one of the following disinfectants at a rate of 0,4 litre/m2 for at least two hours: 30 per cent formalin, four per cent glutaraldehyde, three per cent hydrogen peroxide or one per cent peracetic acid. If necessary, this can be followed by fumigation (see below).
- In a study on the disinfection of B. anhtracis spores it was found that sodium hypochlorite (10 per cent bleach) reduced spores by 90 per cent within 10 minutes and hydrogen peroxide combined with paracetic acid eliminated spores within 20 minutes.148
Fumigation of closed spaces
A room (up to 25 to 30 m3), can be fumigated, after first sealing it to render it airtight, by boiling off four litres of water containing 400 ml of concentrated formalin. It is then left for at least four hours before venting. The room temperature should be at least 15 °C
Anthrax in the laboratory
When handling live B. anthracis in a laboratory, the correct bacteriological procedures for working with hazardous bacteria should be followed.30, 347 These include use of a biohazard safety cabinet for all manipulations and incubation in a separate container from routine specimens. The method of heat fixation of smears of glass slides by passing them through the flame of a Bunsen burner for five to six seconds is not necessarily lethal for anthrax spores, as smears prepared in this way and stored for several years have been shown to contain viable infective spores.316 In general, spills and splashes of infective or potentially infective material on the floor, bench or apparatus should be flooded with a hypochlorite solution containing 10 000 ppm available chlorine and wiped up after 30 minutes’ exposure. The wipings should be placed in an autoclave bin for autoclaving. Bench surfaces should be of impervious material and wiped with the hypochlorite solution after use. Rapid turnover items, such as pipettes and syringes, should be immersed in the hypochlorite solution overnight and then autoclaved. All other items, such as laboratory coats, should be autoclaved.
Animal by-products
If a sample from a consignment of animal by-products, such as bone or carcass meal, wool, hair, or bristles has been tested and found positive for B. anthracis, the consignment must be sterilized. There are various disinfecting protocols, but the preferred one is that of gamma irradiation.33 The D90 for a starting value of 109 spores is 5 kGy, but the D100 is as high as 40 kGy. Bone meal can be sterilized by steam sterilization at 2,7 bar for two hours in a digester of not more than four-ton capacity,78 or by heat sterilization (140 °C) for at least three hours.387 All sterilization methods should be monitored by the subsequent examination of random samples of the material.
Soil
Anthrax-contaminated soil can be treated with a four per cent formaldehyde solution at 5 litres/m2, or a 10 per cent caustic soda solution applied at a rate of 10 litres/m2. Exposure time in all instances should be at least 24 hours.
The effect of treating large areas of soil with sporocidal chemicals, such as potassium permanganate, formaldehyde, glutaraldehyde, dodecyclamine and peracetic acid, has been investigated and it was found that only dodecyclamine fails to kill B. anthracis spores in the soil.226, 228 Formaldehyde (five per cent) is suitable for large-scale application because it is effective and relatively cheap.228 Formaldehyde was used for the decontamination of Gruinard Island, a site that was used during World War II for the first scientific trial of B. anthracis as a potential biological warfare agent. Bacillus anthracis spores persisted in the soil of the island until 1986 when the contaminated part of the island was successfully treated with a five per cent formaldehyde solution to a depth of 15 cm.228
General
Dry heat is less effective than moist heat in killing both the vegetative forms and the spores of B. anthracis. Vegetative forms are killed by a temperature of 60 °C for 30 minutes.47 By contrast, the spores are highly resistant and are inactivated by dry heat at 140 °C for up to three hours, whilst under conditions of moist heat up to 14,2 minutes are necessary at temperatures of 100 to 115 °C. The spores of B. anthracis are generally quite resistant to exposure to alcohols, phenols, quarternary ammonium compounds, ionic or non-ionic surfactants, acids and alkalis.30, 205, 231, 323 High concentrations of chemicals, such as formaldehyde, glutaraldehyde, hydrogen peroxide and peracetic acid, are required to inactivate spores.30, 296
Control of anthrax in wildlife
Anthrax is considered indigenous and an integral part of the ecosystems of some of the larger wildlife areas in southern Africa, such as the Kruger National Park and Etosha National Park82, 215, 309, 362 This makes it debatable whether active control measures should actually be instituted in these areas. In the national parks of South Africa, the policy is to institute active control measures against anthrax only if it affects biodiversity negatively (e.g. by threatening the survival of low density or threatened species), and/or where the actions of humans (such as fencing or the provision of artificial watering points), are providing unnatural impetus to anthrax outbreaks. A general rule of thumb for deciding whether or not to implement control measures in these wildlife areas is that the bigger and more natural and ecologically self-sufficient an area is, the fewer control measures are needed, and vice versa.
However, if the decision is made to control anthrax in the major game reserves, such as the Kruger National Park, most of the control measures, as used for livestock, are difficult, if not impossible, to apply and/or enforce. Earlier investigations were in agreement that parenteral treatment and vaccination of large populations of free-ranging wildlife are largely impractical and, in some instances, almost impossible.55, 56, 142, 273 Nevertheless, herd animals such as plains zebra (Equus quagga), blue wildebeest (Connochaetes taurinus), African buffalo (Syncerus caffer) and American bison which can be corralled or captured, can be vaccinated.56 Long-stemmed, hand-held automatic vaccinating syringes are used from the sides of a crush.260, 269 This method was however difficult and hazardous and an aerial method, immunizing free-ranging wildlife, was subsequently developed in the Kruger National Park.87, 88 This method involves the incorporation of the vaccine in a disposable dart-like projectile syringe which is fired from the sides of a boma/crush or from a helicopter, using a gun and projectile syringe specifically made for the purpose. The dart-syringe is also fitted with a rubber cuff containing dye which effectively marks the animal for subsequent identification. This method of vaccination was later improved by the use of a ballistic implantation method instead of disposable darts.87 It consists of a gun-like device capable of accurately delivering, over short distances, light-weight biodegradable implant projectiles (bio-bullets) containing vaccine. This made it possible to vaccinate large herds of free-ranging wildlife, such as African buffalo, in the “wild”.
Apart from immunization/vaccination, anthrax control procedures which have been used in wildlife situations depend upon the elimination of sources of infection and prevention and mitigation management practices such as: continuous surveillance and an “early warning” system of possible anthrax outbreaks; the fencing-off of anthrax contaminated areas; burning of known anthrax-contaminated vegetation; the location, treating, covering, and/or incineration of anthrax carcasses the replacement of natural waterholes by concrete drinking troughs in which the water can be disinfected. A helicopter or fixed-wing aircraft was found to be virtually essential in locating carcasses and identifying anthrax infected areas under extensive conditions.55, 80, 270 Even if many of these control efforts are instituted, anthrax outbreaks can be notoriously difficult to contain, even in small, highly managed wildlife areas, as discovered during the 2004-2005 anthrax outbreak in Malilangwe, Zimbabwe, where nearly 100 per cent of browsing herbivores were lost despite extreme control efforts.61, 62
References
- AKHMEROV, D. S., KUSOV, V. N. & CHERNOVA, A. A., 1982. Survival of Bacillus anthracis in the tick Dermacentor marginatus. Sbornik Nauchmykh Trudov, Kazanskii Veterinaryi Institut, 101-103.
- ALBRINK, W. S., BROOKS, S. M., BIRON, R. E. & KOPEL, M., 1960. Human inhalation anthrax. The American Journal of pathology, 36, 457-471.
- ALEXANDER, J. E., 1838. An Expedition of Discovery into the Interior of Africa, Vol. I. London: Henry Colburn.
- ANON, 1980. Approved list of bacterial names. International Journal of Systematic Bacteriology., 30, 256.
- ANON, 1994. Anthrax control and research, with special reference to national programme development in Africa: Memorandum from a WHO meeting. Bulletin of the World Health Organization, 72, 13-22.
- ANTONATION, K. S., GRÜTZMACHER, K., DUPKE, S., MABON, P., ZIMMERMANN, F., LANKESTER, F., PELLER, T., FEISTNER, A., TODD, A., HERBINGER, I., DE NYS, H. M., MUYEMBE-TAMFUN, J., KARHEMERE, S., WITTIG, R. M., COUACY-HYMANN, E., GRUNOW, R., CALVIGNAC-SPENCER, S., CORBETT, C. R., KLEE, S. R. & LEENDERTZ, F. H., 2016. Bacillus cereus biovar anthracis causing anthrax in Sub-Saharan Africa—chromosomal monophyly and broad geographic distribution. PLOS Neglected Tropical Diseases, 10(9), e0004923. http://journals.plos.org/plosntds/article?id=10.1371/journal.pntd.0004923.
- ASCOLI, A., 1911. Die Präzipitendiagnose bei Milzbrand. Centrallblatt für Bakteriologie, Parasitenkunde und Infektionskrankheiten, 58, 63-70.
- BAGAMIAN, K. H., ALEXANDER, K. A., HADFIELD, T. L. & BLACKBURN, J. K., 2013. Ante- and postmortem diagnostic techniques for anthrax: rethinking pathogen exposure and the geographic extent of the disease in wildlife. Journal of Wildlife Diseases, 49(4), 786-801.
- BAGAMIAN, K. H., SKRYPNYK, A., RODINA, Y., BEZYMENNYI, M., NEVOLKO, O., SKRYPNYK, V. & BLACKBURN, J. K., 2014. Serological Anthrax Surveillance in Wild Boar (Sus scrofa) in Ukraine. Vector-Borne and Zoonotic Diseases, 14(8), 618-20.
- BARANDONGO, Z. R., MFUNE, J. K. E. & TURNER, W. C., 2018. Herbivore dust bathing behavior and the potential risk of inhalational anthrax. Journal of Wildlife Diseases, 54, 34-44.
- BARNES, J. M., 1947. The development of anthrax following the administration of spores by inhalation. British Journal of Experimental Pathology, 28, 385-394.
- BARRO, A. S., FEGAN, M., MOLONEY, B., PORTER, K., MULLER, J., WARNER, S. & BLACKBURN, J. K., 2016. Redefining the Australian anthrax belt: modeling the ecological niche and predicting the geographic distribution of Bacillus anthracis. PLOS Neglected Tropical Diseases, 10(6):e0004689.
- BARTRAND, T. A., WEIR, M. H. & HAAS, C. N., 2008. Dose‐response models for inhalation of Bacillus anthracis spores: Interspecies comparisons. Risk Analysis: An International Journal, 28, 1115-1124.
- BEAL, F. A., TAYLOR, M. J. & THORNE, C. B., 1962. Rapid lethal effect in rats of a third component found upon fractioning the toxin of Bacillus anthracis. Journal of Bacteriology, 83, 1274-1280.
- BELLAN, S., TURNBULL, P., BEYER, W. & GETZ, W., 2013. Effects of experimental exclusion of scavengers from anthrax-infected herbivore carcasses on Bacillus anthracis sporulation, survival and distribution. Applied and Environmental Microbiology, 79(12), 3756-61.
- BELLAN, S. E., CIZAUSKAS, C. A., MIYEN, J., EBERSOHN, K., KÜSTERS, M., PRAGER, K. C., VAN VUUREN, M., SABETA, C. & GETZ, W. M., 2012. Blacked-back jackal exposure to rabies virus, canine distemper virus and Bacillus anthracis in Etosha National Park, Namibia. Journal of Wildlife Diseases, 48(2), 371-81.
- BERKELY, R. C. W. & GOODFELLOW. M., 1981. The Aerobic Endospore-forming Bacteria: Classification and Identification. Special publication of the Society for General Microbiology, London: Academic Press.
- BEYER, W., BELLAN, S., EBERLE, G., GANZ, H. H., GETZ, W. M., HAUMACHER, R., HILSS, K. A., KILIAN, W., LAZAK, J. & TURNER, W. C., 2012. Distribution and molecular evolution of Bacillus anthracis genotypes in Namibia. PLoS neglected tropical diseases, 6, e1534.
- BEYER, W. & TURNBULL, P. C. B., 2009. Anthrax in animals. Molecular Aspects of Medicine, 30(6), 481-9.
- BEZDENEZHRYKH, O. S. & NIKIFOROV, V. N., 1980. Epidemiological analysis of anthrax in Sverdlovsk. Zhurnal Mikrobiologii, Epidemilogii Immunobiologii, 5, 111-113.
- BLACKBURN, J., MCNYSET, K., CURTIS, A. & HUGH-JONES, M. E., 2007. Modeling the geographic distribution of Bacillus anthracis, the causative agent of anthrax disease, for the contiguous United States using predictive ecologic niche modeling. The American Journal of Tropical Medicine and Hygiene, 77(6), 1103-10.
- BLACKBURN, J. K., 2010. Integrating Geographic Information Systems and Ecological Niche Modeling into Disease Ecology: A Case Study of Bacillus anthracis in the United States and Mexico. In: O'CONNELL, KEVIN P., SKOWRONSKI, EVAN W., SULAKVELIDZE, ALEXANDER, BAKANIDZE, LELA. Emerging and Endemic Pathogens: Advances in Surveillance, Detection and Identificatio, 59-88.
- BLACKBURN, J. K. & GOODIN, D. G., 2013. Differentiation of springtime vegetation indices associated with summer anthrax epizootics in West Texas, USA, deer. Journal of Wildlife Diseases, 49(3), 699-703.
- BLACKBURN, J. K., MATAKARIMOV, S., KOZHOKEEVA, S., TAGAEVA, Z., BELL, L. K., KRACALIK, I. T. & ZHUNUSHOV, A., 2017. Modeling the Ecological Niche of Bacillus anthracis to Map Anthrax Risk in Kyrgyzstan. The American Journal of Tropical Medicine and Hygiene, 96(3), 550-556.
- BLACKBURN, J. K., ODUGBO, M. O., VAN ERT, M., O’SHEA, B., MULLINS, J., PERRENTEN, V., MAHO, A., HUGH-JONES, M. & HADFIELD, T., 2015. Bacillus anthracis Diversity and Geographic Potential across Nigeria, Cameroon and Chad: Further Support of a Novel West African Lineage. PLOS Neglected Tropical Diseases, 9, e0003931.
- BLACKBURN, J. K., VAN ERT, M., MULLINS, J. C., HADFIELD, T. L. & HUGH-JONES, M. E., 2014. The necrophagous fly anthrax transmission pathway: empirical and genetic evidence from wildlife epizootics. Vector-Borne and Zoonotic Diseases, 14(8), 576-83.
- BLENKHARN, J. L. & OAKLAND, D., 1989. Epidemiological analysis of anthrax in Sverdlovsk. Journal of Hospital Infections, 14, 73-78.
- BLOOD, D. C., HENDERSON, J. A. & RADOSTITS, O. M., 1983. Diseases caused by Bacillus spp. In: Veterinary Medicine, 6th edition, London: Baillière Tindall.
- BLOOM, W. L., MCGHEE, W. J., CROMARTJE, W. J. & WATSON, D. W., 1947. Studies on infections with B. anthracis. VI. Physiological changes in experimental animals during the course of infection with B. anthracis. Journal of Infectious Diseases, 80, 137-144.
- BÖHM, R., 1990. Resistance, survival, sterilization and disinfection of spores of Bacillus anthracis. Salisbury Medical Bulletin Special Supplement, 68, 99-101.
- BÖHM, R. & SPÄTH, G., 1990. The taxonomy of Bacillus anthracis according to DNA-DNA hybridization and G+C content. Salisbury Medical Bulletin Special Supplement, 68, 29-31.
- BONVENTRE, P. F., SUEOKA, W., TRUE, C. W., KLEIN, F. & LINCOLN, R. L., 1967. Attempts to implicate the central nervous system as a primary site of action of Bacillus anthracis lethal toxin. Federation Proceedings, 26, 1549-1553.
- BOWEN, J. E., MANCHEE, R. J., WATSON, S. & TURNBULL, P. C. B., 1986. Inactivation of Bacillus anthracis vegetative cells and spores by gamma irradiation. In: TURNBULL, P.C.B., (ed.). Proceedings of the International Workshop on Anthrax, 19–21 September 1995, Winchester. Salisbury Medical Bulletin No. 87, Special Suppl:, 70–72.
- BRAACK, L. E. O. & DE VOS, V., 1990. Feeding habits and flight range of blow-flies (Chrysomyia spp.). Onderstepoort Journal of Veterinary Research, 57, 141-142.
- BRAACK, L. E. O. & RETIEF, P. F., 1986. Dispersal, density and habitat preference of the blowfly Chrysomyia marginalis Diptera Calliphoridae. Onderstepoort Journal of Veterinary Research, 53, 13-18.
- BRACHMAN, P. S., 1966. Human anthrax in the United States. Antimicrobial Agents and Chemotherapy. USA, American Society for Microbiology.
- BRACHMAN, P. S., 1981. Inhalation anthrax. Annals of the New York Academy of Sciences, 353, 83-93.
- BRACHMAN, P. S. & FEKETY, F. R., 1958. Industrial anthrax. Annals of the New York Academy of Sciences, 70, 574-584.
- BRANFORD, W. C., 1876. Meltziekte or splenic apoplexy. Annual Report of the College of Veterinary Surgeons Cape of Good Hope, 19-20.
- BRAUN, P., GRASS, G., ACETI, A., SERRECCHIA, L., AFFUSO, A., MARINO, L., GRIMALDI, S., PAGANO, S., HANCZARUK, M., GEORGI, E., NORTHOFF, B., SCHÖLER, A., SCHLOTER, M., ANTWERPEN, M. & FASANELLA, A., 2015. Microevolution of Anthrax from a Young Ancestor (M.A.Y.A.) Suggests a Soil-Borne Life Cycle of Bacillus anthracis. PLOS ONE, 10, e0135346.
- BRENNAN, A. D. J., 1953. Anthrax with special reference to the recent outbreak in pigs. The Veterinary Record, 65, 255-258.
- BREWER, C. R., MCCULLOUGH, W. G., MILLS, R. C., ROESSLER, W. G., HERBST, E. J. & HOWE, A. F., 1946. Studies on the nutritional requirements of Bacillus anthracis. Archives of Biochemistry and Biophysics, 19, 65-75.
- BRUNSDON, J. R., 1968. Unusual features in anthrax outbreaks. The Veterinary Record, 82, 747-748.
- BRYDEN, H. B. & DE VOS, V., 1998. Anthrax in the Kruger National Park, South Africa: The effect of different wild animals’ sera on the in vitro germination of Bacillus anthracis spores: Preliminary report. Proceedings of the ARC-Onderstepoort OIE International Congress with WHO-Cosponsorship on Anthrax, Brucellosis, CBPP, Clostridial and Mycobacterial Diseases, Berg-en Dal, Kruger National Park, 25-32.
- BUCK, C. A., ANACKER, R. L., NEWMAN, F. S. & EISENSTARK, A., 1963. Phage isolated from lysogenic Bacillus anthracis. Journal of Bacteriology, 85, 1423-1430.
- BURIRO, S. N., 1980. Experimental inoculation of bacterial isolates obtained from Argas (persicargas) persicus in poultry. Zeitschrift für Angewandte Entomologie, 89, 324-330.
- BUXTON, A. & FRASER, G., 1977. Bacillus. In: BUXTON, A. & FRASER, G., (eds). Animal Microbiology, Oxford: Blackwell Scientific Publications.
- CAMPBELL, D. T., 1975. III. “Degrees of Freedom” and the Case Study. Comparative Political Studies, 8, 178-193.
- CARMAN, J. A., HAMBLETON, P. & MELLING, J., 1985. Bacillus anthracis. Isolation and identification of micro-organisms of medical and veterinary importance. In: COLLINS, C.H. & GRANGE, J.M., (eds). Society for Applied Bacteriology, Technical Series No. 21, London: Wolfe Medical Publications Ltd.
- CARR, E. A. & REW, R. R., 1957. Recovery of Bacillus anthracis from the nose and throat of apparently healthy workers. Journal of Infectious Diseases, 100, 169-171.
- CARTWRIGHT, M. E., MCCHESNEY, A. E. & JONES, R. L., 1987. Vaccination related anthrax in three llamas. Journal of the American Veterinary Medical Association, 191, 715-716.
- CHARNEY, J. F. W. P. & HEGARTY, C. P., 1951. Parasites and diseases of bison in Canada. Journal of Bacteriology, 62, 145-148.
- CHEN, W. J., LAI, S. J., YANG, Y., LIU, K., LI, X. L., YAO, H. W., LI, Y., ZHOU, H., WANG, L. P., MU, D., YIN, W. W., FANG, L. Q., YU, H. J. & CAO, W. C., 2016. Mapping the Distribution of Anthrax in Mainland China, 2005–2013. PLOS Neglected Tropical Diseases, 10, e0004637.
- CHIKEREMA, S. M., PFUKENJI, D. M., MATOPE, G. & BHEBHE, E., 2012. Temporal and spatial distribution of cattle anthrax outbreaks in Zimbabwe between 1967 and 2006. Tropical Animal Health and Production, 44, 63-70.
- CHOQUETTE, L. P. E. & BROUGHTON, E., 1981. Anthrax. In: DAVIS, J.W., KARSTAD, L.H. & TRAINER, D.O., (eds). Infectious Diseases of Wild Mammals, 2nd edition, Ames, Iowa: Iowa State University Press.
- CHOQUETTE, L. P. E., BROUGHTON, E., CURRIER, A. A. C. J. G. & NOVAKOWSKI, N. S., 1972. Parasites and diseases of bison in Canada. Canadian Field Naturalist, 86, 127-132.
- CIZAUSKAS, C. A., BELLAN, S. E., TURNER, W. C., VANCE, R. E. & GETZ, W. M., 2014. Frequent and seasonally variable sublethal anthrax infections are accompanied by short-lived immunity in an endemic system. Journal of Animal Ecology, (83), 1078-90.
- CIZAUSKAS, C. A., TURNER, W. C., PITTS, N. & GETZ, W. M., 2015. Seasonal Patterns of Hormones, Macroparasites, and Microparasites in Wild African Ungulates: The Interplay among Stress, Reproduction, and Disease. PLOS One, 10(4), e0120800.
- CIZAUSKAS, C. A., TURNER, W. C., WAGNER, B., KÜSTERS, M., VANCE, R. E. & GETZ, W. M., 2014. Gastrointestinal helminths may affect host susceptibility to anthrax through seasonal immune trade-offs. BMC Ecology, 14, 27.
- CLARK, R., 1938. Speculations on the incidence of anthrax in bovines. Journal of the South African Veterinary Medical Association, 9, 5-12.
- CLEGG, S., 2006. Preparedness for anthrax epizootics in wildlife areas (conference summary). Emerging Infectious Diseases.
- CLEGG, S. B., TURNBULL, P. C. B., FOGGIN, C. M. & LINDEQUE, P. M., 2007. Massive outbreak of anthrax in wildlife in the Malilangwe Wildlife Reserve, Zimbabwe. Veterinary Record, 160(4), 113-8.
- COGGINS, C. H., 1963. Weapons of mass destruction. Military Review, 42, 43-50.
- COHN, F., 1875. Untersuchungen über Bacterien. IV Beitrage zur Biologie der Bacillen Beitrge zur Biologie der Pflanzen, 2, 249-277.
- COLLIER, R. J. & YOUNG, J. A. T., 2003. Anthrax toxin. Annual Review of Cell and Developmental Biology, 19(1), 45-70.
- CONSTABLE, A., 1991. Chemical and biological weapons. Time 4 February.
- COUNSIL, R., 1995. The effects of anthrax on endangered African wild dogs (Lycaon pictus). Journal of Zoology, London, 1, 32-34.
- CREEL, S., CREEL, N. M., MATOVELO, J. A., MTAMBO, M. M. A., BATAMUZI, E. K. & COOPER, J. E., 1995. The effects of anthrax on endangered African wild dogs (Lycaon pictus). Journal of Zoology, London, 236, 199-209.
- CROMARTIE, W. J., BLOOM, W. L. & WATSON, D. W., 1947. Studies on infection with Bacillus anthracis. I. A histopathological study of skin lesions produced by B. anthracis in susceptible and resistant animal species. Journal of Infectious Diseases, 80, 1–13.
- CRUICKSHANK, R., DUGUID, J. P., MARMION, B. P. & SWAIN, R. H. A., 1975. Medical Microbiology, 12th edition. Vol. II, Edinburgh: Churchill, Livingstone.
- CULLEY, N., PINSON, D., CHAKRABARTY, A., MAYO, M. & SM, 2005. Pathophysiological manifestations in mice exposed to anthrax lethal toxin. Infection and Immunity, 73(10), 7006-10.
- DAHLGREN, C. M., BUCHANAN, L. M., DECKER, H. M., FREED, S. W., PHILLIPS, C. R. & BRACHMAN, P. S., 1960. Bacillus anthracis aerosols in goat hair processing mills. American Journal of Hygiene, 72, 6-23.
- DAVIES, D. G., 1960. The influence of temperature and humidity or spore formation and germination in Bacillus anthracis. Journal of Hygiene, 58, 177-186.
- DAVIES, G. O., 1947. Gaiger and Davies’ Veterinary Pathology and Bacteriology. 3rd edition, London: Ballière, Tindall and Cox.
- DAVIES, J. C. A., 1982. A major epidemic of anthrax in Zimbabwe. Part I. Central African Journal of Medicine, 28, 291-298.
- DAVIES, J. C. A., 1983. Anthrax and flies. Zimbabwe Science News, 17, 11-12.
- DAVIES, J. C. A., 1983. A major epidemic of anthrax in Zimbabwe. Part II. Distribution of cutaneous lesions. Central African Journal of Medicine, 29, 8-12.
- DE KOCK, G. V. D. W., STERNE, M. & ROBINSON, E. M., 1940. Sterilization of bone meal. Journal of the South African Veterinary Medical Association, 11, 138-141.
- DE VOS, V., 1974. Vultures carry yet curtail anthrax. Journal of the South African Veterinary Medical Association, 44, 35.
- DE VOS, V., 1990. The ecology of anthrax in the Kruger National Park, South Africa. Salisbury Medical Bulletin (Special Supplement), 68, 19-23.
- DE VOS, V., 1994. Report on an anthrax outbreak in Lesotho. Report to the FAO, Rome.
- DE VOS, V., 1998. Anthrax in the Kruger National Park: An ecological approach to the question whether anthrax is indigenous to the Kruger National Park. Proceedings of the ARC-Onderstepoort OIE International Congress with WHO-Cosponsorship on Anthrax, Brucellosis, CBPP, Clostridial and Mycobacterial Diseases, Berg-en Dal, Kruger National Park, 16-21.
- DE VOS, V., 1998. The isolation of viable and pathogenic Bacillus anthracis organisms from 200 ± 50 year old bones from the Kruger National Park. 22-24.
- DE VOS, V., 2000. Unpublished data.
- DE VOS, V. & BRYDEN, H. B., 1995. The epidemiology of a major anthrax outbreak in the Kruger National Park. Winchester, UK, 25-26.
- DE VOS, V. & BRYDEN, H. B., 1996. Anthrax in the Kruger National Park: Temporal and spatial patterns of disease occurrence. Salisbury Medical Bulletin (Special Supplement), 87, 26–30.
- DE VOS, V. & SCHEEPERS, G. J., 1996. Remote mass vaccination of large free-ranging wild animals for anthrax using Sterne spore vaccine. Salisbury Medical Bulletin Special Supplement, 87, 116-121.
- DE VOS, V. V. R. G. L. & KLOPPERS, J. J., 1973. Anthrax immunization of free-ranging roan antelope (Hippotragus equinus) in the Kruger National Park. Koedoe, 16, 11-25.
- DEY, R., HOFFMAN, P. S. & GLOMSKI, I. J., 2012. Germination and amplification of anthrax spores by soil dwelling amoeba. Applied and Environmental Microbiology, 78, 8075-81.
- DIETVORST, D. C. E., 1996. Educational material on anthrax for villages in western Zambia. Salisbury Medical Bulletin No Special supplement, 87, 104-106.
- DIETVORST, D. C. E., 1996. Farmers’ attitudes towards the control and prevention of anthrax in Western Province, Zambia. Salisbury Medical Bulletin (Special supplement), 87, 102-103.
- DIRCKX, J. M., 1981. Virgil on anthrax. American Journal of Dermatopathology, 3, 191-195.
- DIXON, 1911. Annual Report, Principal Veterinary Surgeon, Transvaal, Union of South Africa.
- DONG, S. L., 1990. Progress in the control and research of anthrax in China. Salisbury Medical Bulletin Special Supplement, 68, 104-105.
- DRAGON, D. C., BADER, D. E., MITCHELL, J. & WOOLLEN, N., 2005. Natural Dissemination of Bacillus anthracis Spores in Northern Canada. Applied and Environmental Microbiology, 71, 1610.
- DRAGON, D. C. & RENNIE, R. P., 1995. The ecology of anthrax spores: Tough but not invincible. Canadian Veterinary Journal, 36, 295-301.
- DUESBURY, N. S. & VAN DE, W. G. F., 1999. Anthrax lethal factor causes proteolytic inactivation of mitogen-activated protein kinase-kinase. Journal of Applied Microbiology, 87, 289-293.
- DUESBURY, N. S., WEBB, C. P., LEPPLA, S. H., GORDON, V. M., KLIMPEL, K. R., COPELAND, T. D., AHN, N. G., OSKARSSON, M. K., FUKASAWA, K., PAULL, K. D. & VANDE WOUDE, G. F., 1998. Proteolytic inactivation of MAP-kinase-kinase by anthrax lethal factor. Science, 280, 734-735.
- EBEDES, H., 1976. Anthrax epizootics in Etosha National Park. Madoqua, 10, 99-118.
- EBEDES, H., 1981. A new look at anthrax In: FOWLER, M.W., (ed.). Proceedings of the Fourth International Conference of the Wildlife Disease Association, Sydney, Australia.
- ENGEL, W. F., 1998. Achieving ground truth on anthrax in a trusted international anthrax early warning framework. Proceedings of the ARC-Onderstepoort Congress with WHO-Cosponsorship on Anthrax Clostridial and Mycobacterial Diseases Bergen Park, 41-44.
- EPSTEIN, H., 1971. The Origin of the Domestic Animals of Africa. I & II, New York: Africana Publishing Corporation.
- EURICH, F. W., 1933. Some notes on industrial anthrax. British Medical Journal, 2, 50-53.
- EZZELL, J. W., 1986. Bacillus anthracis. In: GYLES, C.L. & THOEN, C.O., (eds.). Pathogenesis of Bacterial Infections in Animals, Ames, Iowa: Iowa State University Press.
- EZZELL, J. W., IVINS, B. E. & LEPPLA, S. H., 1984. Immunoelectrophoretic analysis, toxicity, and kinetics of in vitro production of the protective antigen and lethal factor components of Bacillus anthracis toxin. Infection and Immunity, 45, 761-767.
- FAO., 2016. Anthrax outbreaks: a warning for improved prevention, control and heightened awareness. Empres Watch, 37, http://www.fao.org/3/a-i6124e.pdf.
- FARRAR, W. E., 1994. Anthrax: virulence and vaccines. Annals of Internal Medicine, 121, 379–380.
- FASANELLA, A., TONELLO, F., GAROFOLO, G., MURARO, L., CARATTOLI, A., ADONE, R. & MONTECUCCO, C., 2008. Protective activity and immunogenicity of two recombinant anthrax vaccines for veterinary use. Vaccine, 26(45), 5684-5688.
- FEELEY, J. C. & PATTON, C. M., 1980. Bacillus. In: LENNETTE, E.H., BALOWS, A., HAUSLER, W.J. & TRUANT, J.P., (eds.). Manual of Clinical Microbiology, 3rd edition, Washington D.C.: American Society for Microbiology.
- FERGUSON, L. C., 1981. Anthrax. In: LEMAN, A.D., GLOCK, R.D., MENGELING, W.L., PENNY, R.H.C., SCHOLL, E. & STRAW, B., (eds.). Diseases of Swine, 5th edition, Ames, Iowa: Iowa State University Press.
- FISH, D. C. & LINCOLN, R. E., 1968. In vivo-produced anthrax toxin. Journal of Bacteriology, 95, 919-924.
- FORSHAW, D., HIGGS, A. R. B., MOIR, D. C., ELLIS, T. M. & LINKS, I. J., 1996. Anthrax in cattle in southern Western Australia. Australian Veterinary Journal, 74, 391-393.
- FRIEDLANDER, A. M., WELKOS, S. L., PITT, M. L. M. & ET AL., 1993. Postexposure prophylaxis against experimental inhalation anthrax. Journal of Infectious Diseases, 167, 1239-1243.
- GAINER, R. & SAUNDERS, JR., 1989. Aspects of the epidemiology of anthrax in Wood Buffalo National Park and environs. Canadian Veterinary Journal, 30(12), 953-6.
- GAINER, R. S., 1987. Epizootiology of anthrax and Nyasa wildebeest in the Selous Game Reserve, Tanzania. Journal of Wildlife Diseases, 23, 175-178.
- GANZ, H., KARAOZ, U., GETZ, W., VERSFELD, W. & EL, B., 2012. Diversity and structure of soil bacterial communities associated with vultures in an African savanna. Ecosphere, 3(6), art47.
- GATES, C. C., ELKIN, B. T. & DRAGON, D. C., 1995. Investigation, control and epizootiology of anthrax in a geographically isolated, free-roaming bison population in northern Canada. Canadian Journal of Veterinary Research, 59, 256-264.
- GIBSON, T. & GORDON, R. E., 1974. Genus Bacillus. In: BUCHANAN, R. E. & GIBBONS, N. E., (eds.). Bergey’s Manual of Determinative Bacteriology., 8th edition, Baltimore: Williams and Wilkins.
- GILL, I. J., 1982. Antibiotic therapy in the control of an outbreak of anthrax in dairy cows. Australian Veterinary Journal, 58, 214-215.
- GILLESPIE, J. H. & TIMONEY, J. F., 1981. The Genus Bacillus. 7th edition, Ithaca, London: Comstock Publishing Associates, Division of Cornell University Press.
- GIOVANARDI, A., 1931. Untersuchungen über die Pathogenese des Darmmilzbrandes. Krankheitsforschung, 9, 13-33.
- GIRAULT & ET AL., 2014. High-throughput sequencing of Bacillus anthracis in France: investigating genome diversity and population structure using whole-genome SNP discovery. BMC Genomics, 15, 288. http://www.biomedcentral.com/1471-2164/15/288.
- GLADSTONE, G. P., 1946. Immunity to anthrax. Protective antigen present in cell-free culture filtrates. British Journal of Experimental Pathology, 27, 394-418.
- GLASSMAN, H. N., 1966. Discussion: Industrial inhalation of anthrax. Bacteriological Reviews, 30, 657.
- GLEISER, C. A., 1967. Pathology of anthrax infection in animal hosts. Federation Proceedings, 26, 1518-1521.
- GLOMSKI, I. J., PIRIS-GIMENEZ, A., HUERRE, M., MOCK, M. & GOOSSENS, P. L., 2007. Primary Involvement of Pharynx and Peyer's Patch in Inhalational and Intestinal Anthrax. PLOS Pathogens, 3(6), e76.
- GOLD, H., 1967. Treatment of anthrax. Federation Proceedings, 26, 1563-1568.
- GORDIN, M. D., 1997. The anthrax solution: The Sverdlovsk incident and the resolution of a biological weapons convention. Journal of the History of Biology, 30, 441-480.
- GORDON, R. E., 1973. The Genus Bacillus. In: LASKIN, A. I. & LECHEVALIER, H. A., (eds.). Handbook of Microbiology, I, Cleveland, Ohio: CRC Press.
- GORDON, R. E., 1981. One hundred and seven years of the genus Bacillus. In: BERKELY, R.C.W. & GOODFELLOW, M., (eds.). The Aerobic Endosporeforming Bacteria: Classification and Identification, London: Academic Press.
- GORDON, R. E., HAYNES, W. C. & PANG, C. H. N., 1973. The Genus Bacillus. Agricultural Research Service, Agriculture Handbook, 427.
- GRAHAM-SMITH, G. S., 1913. Flies and Disease: Non-blood Sucking Flies. Cambridge: Cambridge University Press.
- GRAY, C. E., 1906, 1907, 1910, 1914, 1918. Annual Reports, Principal Veterinary Surgeon, Transvaal, Union of South Africa.
- GREEN, B. D., BATTISTI, L., KOEHLER, T. M., THORNE, C. B. & IVINS, B. E., 1985. Demonstration of a casule plasmid in Bacillus anthracis. Infection and Immunity, 49, 291-297.
- GREENBERG, B., 1971. Flies and Disease. I, Princeton, New Jersey: Princeton University Press.
- GREENBERG, B., 1973. Flies and Disease. II, Princeton, New Jersey: Princeton University Press.
- HAHN, U. K., ALEX, M., CZERNY, C. P., BÖHM, R. & BEYER, W., 2004. Protection of mice against challenge with Bacillus anthracis STI spores after DNA vaccination. International Journal of Medical Microbiology, 294, 35-44.
- HAMBLETON, P., CARMAN, J. A. & MELLING, J., 1984. Anthrax: The disease in relation to vaccines. Vaccine, 2, 125-132.
- HAMPSON, K., LEMBO, T., BESSELL, P., AUTY, H., PACKER, C., HALLIDAY, J., BEESLEY, C. A., FYUMAGWA, R., HOARE, R., ERNEST, E., MENTZEL, C., METZGER, K. L., MLENGEYA, T., STAMEY, K., ROBERTS, K., WILKINS, P. P. & CLEAVELAND, S., 2011. Predictability of anthrax infection in the Serengeti, Tanzania. The Journal of Applied Ecology, 48, 1333-1344.
- HANNA, P., 1998. Anthrax pathogenesis and host response. Current Topics in Microbiology and Immunology, 225, 13-55.
- HANSON, R. P., 1959. The earliest account of anthrax in man and animals in North America. Journal of the American Veterinary Medical Association, 135, 463-465.
- HARTHOORN, A. M. & LOCK, J. A., 1960. A note on the prophylactic vaccination of wild animals. The British veterinary journal, 116, 252-254.
- HASSIM, A., DEKKER, E. H., BYARUHANGA, C., REARDON, T. & VAN HEERDEN, H., 2017. A retrospective study of anthrax on the Ghaap Plateau, Northern Cape province of South Africa, with special reference to the 2007–2008 outbreaks. Onderstepoort Journal of Veterinary Research, 84(1), a1414. https://doi.org/10.4102/ojvr.v84i1.1414.
- HAVARUA, Z., TURNER, W. C. & MFUNE, J. K. E., 2014. Seasonal variation in foraging behaviour of plains zebra (Equus quagga) may alter contact with the anthrax bacterium (Bacillus anthracis). Canadian Journal of Zoology, 92(4), 331-7.
- HENDERSON, D. W., PEACOCK, S. & BELTON, F. C., 1956. Observations on the prophylaxis of experimental pulmonary anthrax in the monkey. Journal of Hygiene, 54, 28-36.
- HENDERSON, I., 1996. Fingerprinting Bacillus anthracis strains. Salisbury Medical Bulletin Special Supplement, 87, 55-58.
- HENDERSON, I. D. & TURNBULL, P. C. B., 1994. Differentiation of Bacillus anthracis from other Bacillus cereus group bacteria with the PCR. International Journal of Systematic Bacteriology, 44, 99-105.
- HENINGER, S. J., ANDERSON, C. A., BELTZ, G. & ONDERDONK, A. B., 2009. Decontamination of Bacillus anthracis Spores: Evaluation of Various Disinfectants. Applied biosafety : Journal of the American Biological Safety Association, 14, 7-10.
- HENNING, M. W., 1956. Anthrax. In: Animal Diseases in South Africa. 3rd edition, South Africa: Central News Agency Ltd.
- HENNING, O., 1893. Annual Report of the College of Veterinary Surgeons, C.G.H.
- HENTON, M. M. & BRIERS, G. F., 1998. Anthrax spores isolated above burning carcases. Proceedings of the ARC-Onderstepoort OIE International Congress with WHO-Cosponsorship on Anthrax, Brucellosis, CBPP, Clostridial and Mycobacterial Diseases, Berg-en Dal, Kruger National Park, 37-39.
- HERING, D., THOMPSON, W., HEWETSON, J., LITTLE, S., NORRIS, S. & PACE-TEMPLETON, J., 2004. Validation of the anthrax lethal toxin neutralization assay. Biologicals, 32, 17-27.
- HOUSTON, D. C. & COOPER, J. E., 1975. The digestive tract of the whiteback griffon vulture and its role in disease transmission among wild ungulates. Journal of Wildlife Diseases, 11, 306-313.
- HUGH-JONES, M. & BLACKBURN, J., 2009. The ecology of Bacillus anthracis. Molecular Aspects of Medicine, 30(6), 356-67.
- HUGH-JONES, M. E., 1990. Global trends in the incidence of anthrax in livestock. Salisbury Medical Bulletin Special Supplement, 68, 2-4.
- HUGH-JONES, M. E., 1996. World situation 1993/94. Salisbury Medical Bulletin Special Supplement, 87, 1-2.
- HUGH-JONES, M. E. & DE VOS, V., 2002. Anthrax and wildlife. Scientific and Technical Review of the Office Internationale des Epizooties, 21(2), 359–383.
- HUTCHEON, D., 1880, 1881, 1882, 1883, 1884, 1896, 1898, 1903. Annual Reports of the College of Veterinary Surgeon. Cape of Good Hope.
- HUTYRA, F., MAREK, J. & MANNINGER, R., 1938. Special Pathology and Therapeutics of the Diseases of Domestic Animals, 4th edition, London: Baillière, Tindall and Cox.
- IKEDE, B. O., FALADE, S. & GOLDING, R. R., 1976. Anthrax in captive carnivores in Ibadan, Nigeria. Journal of Wildlife Diseases, 12, 130-132.
- IVINS, B. E. & WELKOS, S. L., 1988. Recent advances in the development of an improved, human anthrax vaccine. European Journal of Epidemiology, 4, 12.
- JACKSON, F. C., WRIGHT, G. C. & ARMSTRONG, J., 1957. Immunization of cattle against experimental anthrax with alum-precipitated protective antigen or spore vaccine. American Journal of Veterinary Research, 18, 771-777.
- JACKSON, S. R., 1930. The introduction into Great Britain of anthrax infection by means of products of animal origin. Journal of Comparative Pathology and Therapeutics, 43, 95-98.
- JÃGER, H. G., BOOKER, H. H. & HÃŒBSCHLE, O. J. B., 1990. Anthrax in cheetahs (Acinonyx jubatus) in Namibia. Journal of Wildlife Diseases, 26, 423-424.
- JANG, J., CHO, M., CHUN, J., CHO, M., PARK, J., OH, H., YOO, C. & RHIE, G., 2011. The poly-γ-d-glutamic acid capsule of Bacillus anthracis enhances lethal toxin activity. Infection and Immunity, 79, 3846-3854.
- JONES, W. I. & KLEIN, F., 1967. In vivo growth and distribution of anthrax bacilli in resistant, susceptible and immunized hosts. Journal of Bacteriology, 94, 600-608.
- JOYNER, T. A., LUKHNOVA, L., PAZILOV, Y., TEMIRALYEVA, G., HUGH-JONES, M. E., AIKIMBAYEV, A. & BLACKBURN, J. K., 2010. Modeling the potential distribution of Bacillus anthracis under multiple climate change scenarios for Kazakhstan. PLOS One, 5(3), e9596.
- KAUFMANN, A. F., MELTZER, M. I. & SCHMID, G. P., 1997. The economic impact of a bioterrorist attack. Emerging Infectious Diseases, 3, 83-94.
- KEHOE, D., 1917. Anthrax in South Africa. 5th and 6th Reports of the Director of Veterinary Education and Research, Union of South Africa.
- KEIM, P., KALIF, A., SCHUPP, J., HILL, K., TRAVIS, S. E., RICHMOND, K., ADAIR, D. M., HUGH-JONES, M., KUSKE, C. R. & JACKSON, P., 1997. Molecular evolution and diversity in Bacillus anthracis as detected by amplified fragment length polymorphism markers. Journal of Bacteriology, 179, 818-824.
- KEIM, P., PRICE, L. B., KLEVYTSKA, A. M., SMITH, K. L., SCHUPP, J. M., OKINAKA, R., JACKSON, P. J. & HUGH-JONES, M. E., 2000. Multiple-locus variable-number tandem repeat analysis reveals genetic relationships within Bacillus anthracis. Journal of Bacteriology, 182, 2928-2936.
- KEIM, P. & SMITH, K. L., 2002. Bacillus anthracis evolution and epidemiology. Current Topics in Microbiology and Immunology, 271, 21.
- KEIM, P., VAN ERT, M. N., PEARSON, T., VOGLER, A. J., HUYNH, L. Y. & WAGNER, D. M., 2004. Anthrax molecular epidemiology and forensics: using the appropriate marker for different evolutionary scales. Infection, Genetics and Evolution, 4(3), 205-13.
- KENEFIC, L. J., PEARSON, T., OKINAKA, R. T., SCHUPP, J. M., WAGNER, D. M., RAVEL, J., HOFFMASTER, A. R., TRIM, C. P., CHUNG, W., BEAUDRY, J. A., FOSTER, J. T., MEAD, J. I. & KEIM, P., 2009. Correction: Pre-Columbian Origins for North American Anthrax. PLOS ONE, 4(5), 10.1371/annotation/9e8af820-8037-4f98-86b3-6581e16c2ae6. http://journals.plos.org/plosone/article?id=10.1371/journal.pone.0004813.
- KEPPIE, J., HARRIS-SMITH, P. W. & SMITH, H., 1963. The chemical basis of the virulence of Bacillus anthracis. IX: Its aggressions, and their mode of action. British Journal of Experimental Pathology, 44, 446-453.
- KEPPIE, J., SMITH, H. & HARRIS-SMITH, P. W., 1955. The chemical basis of the virulence of Bacillus anthracis. III: The role of the terminal bacteraemia in death of guinea-pigs from anthrax. British Journal of Experimental Pathology, 36, 315-322.
- KHMALADZA & ET AL., 2014.
- KIRBY, P. R., 1939. The Diary of Dr. Andrew Smith, Director of the ‘Expedition for Exploring Central Africa’, 1, Cape Town: The Van Riebeeck Society.
- KLEE, S. R., BRZUSZKIEWICZ, E. B., NATTERMANN, H., BRÜGGEMANN, H., DUPKE, S., WOLLHERR, A., FRANZ, T., PAULI, G., APPEL, B., LIEBL, W., COUACY-HYMANN, E., BOESCH, C., MEYER, F., LEENDERTZ, F. H., ELLERBROK, H., GOTTSCHALK, G., GRUNOW, R. & LIESEGANG, H., 2010. The genome of a Bacillus isolate causing anthrax in chimpanzees combines chromosomal properties of B. cereus with B. anthracis virulence plasmids. . PLOS One, 5(7), e10986.
- KLEIN, F., HAINES, B. W., MAHLANDT, B. G., DEARMON, I. A. & LINCOLN, R. E., 1963. Dual nature of resistance mechanisms as revealed by studies of anthrax septicemia. Journal of Bacteriology, 85, 1032-1033.
- KLEIN, F., MAHLANDT, B. G., LINCOLN, R. E., DEARMON, I. A. & FERNELIUS, A. L., 1961. Immunization as a factor affecting the course of septicaemic anthrax. Science, 133, 1021-1022.
- KLEIN, F., WALKER, J. S., FITZPATRICK, D. F., LINCOLN, R. E., MAHLANDT, B. G., JONES, W. I. J., DOBBS, J. P. & HENDRIX, K. J., 1966. Pathophysiology of anthrax. Journal of Infectious Diseases, 116, 123-138.
- KLEMM, D. M. & KLEMM, W. R., 1959. A history of anthrax. Journal of the American Veterinary Medical Association, 135, 458-462.
- KLIMPEL, K. R., ARORA, N. & LEPPLA, S. H., 1994. Anthrax toxin lethal factor contains a zinc metalloprotease consensus sequence, which is required for lethal toxin activity. Molecular microbiology, 13, 1093-1100.
- KNIGHT, B. C. J. G. & PROOM, H., 1950. A comparative survey of the nutrition and physiology of mesophilic species in the genus Bacillus. Journal of General Microbiology, 4, 508-538.
- KNISELY, R. F., 1966. Selective medium for Bacillus anthracis. Journal of Bacteriology, 92, 784-786.
- KNUDSON, G. B., 1986. Treatment of anthrax in man: History and current concepts. Military medicine, 151, 71-77.
- KNUDSON, G. B. & TURELL, M. J., 1987. Mechanical transmission of Bacillus anthracis by the stable fly Stomoxys calcitrans. Abstracts of the Annual Meeting of the American Society of Microbiology, 87, 355.
- KOBUCH, W. E., DAVIS, J., FLETSCHER, K., ISAACSON, M. & TURNBULL, P. C. B., 1990. A clinical and epidemiological study of 621 patients with anthrax in western Zimbabwe. Salisbury Medical Bulletin (Special Supplement), 68, 34-38.
- KOCH, R., 1876. The aetiology of anthrax based on the ontogeny of the anthrax Bacillus. Medical Classics (1938), 2, 745–820. Originally published in: Beiträge zür Biologie der Pflanzen, 277–310.
- KOLONIN, G. V., 1969. Nosogeography of anthrax in the USSR in association with its landscape epizootiology. English translation Zhurnal Mikrobiologii pidemiologii i Immunobiologii, 46, 91-97.
- KOLONIN, G. V., 1970. Evolution of anthrax. Peculiarities of circulation of the causative agent and the origin of the disease English translation Zhurnal Mikrobiologii pidemiologii i Immunobiologii, 47, 98-102.
- KOLONIN, G. V., 1971. Evolution of anthrax. History of spread of the disease English translation Zhurnal Mikrobiologii pidemiologii i Immunobiologii, 48, 118-122.
- KOLSTØ, A., TOURASSE, N. J. & ØKSTAD, O. A., 2009. What sets Bacillus anthracis apart from other Bacillus species. Annual Review of Microbiology, 63, 451-76.
- KRANEVELD, F. C. & DJAENOEDIN, R., 1940. Experiments on the transmission of anthrax by Tabanus rubidus to horses and buffaloes. Veeartsenykundig Mededelingen, 83, 42.
- KRANEVELD, F. C. & MANSJOER, M., 1939. De miltvuurbacil in het digestie-apparaat van den Tabanus rubidus wied. NederlandsIndische Bladen Voor Diergeneeskunde, 51, 62-75.
- KRIEK, N. P. J. & DE VOS, V., 1996. Species differences in the pathology of wildlife in the Kruger National. Salisbury Medical Bulletin (Special Supplement), 87, 82.
- KRISHNA, R. N. S. & MOHIYUDEEN, S., 1958. Tabanus flies as transmitters of anthrax—a field experience. The Indian Veterinary Journal, 35, 348- 353.
- KUSOV, V. N., AKHMEROV, D. S. & CHERNOVA, A. A., 1983. Role of blood sucking mosquitoes in the transmission of anthrax. Sbornik Nauchnykh Trudov, Kazanskii Veterinarnyi Institut, 120-126.
- LAMANNA, C., 1967. The anthrax question. Federation Proceedings, 26, 1491-1492.
- LAMBERT, J., 1882. Horse-sickness or anthrax in South Africa. Veterinary Journal, 14, 118-128.
- LAWRENCE, J. A., FOGGIN, C. M. & NORVAL, R. A. I., 1980. The effects of war on the control of diseases of livestock in Rhodesia (Zimbabwe). Veterinary Record, 107, 82–85.
- LE FLÈCHE, P., HAUCK, Y., ONTENIENTE, L., PRIEUR, A., DENOEUD, F., RAMISSE, V., SYLVESTRE, P., BENSON, G., RAMISSE, F. & VERGNAUD, G., 2001. A tandem repeats database for bacterial genomes: application to the genotyping of Yersinia pestis and Bacillus anthracis. BMC Microbiology, 1, 2.
- LEMBO, T., HAMPSON, K., AUTY, H., BEESLEY, C. A., BESSELL, P., PACKER, C., HALLIDAY, J., FYUMAGWA, R. D., HOARE, R., ERNEST, E., MENTZEL, C., MLENGEYA, T., STAMEY, K., WILKINSON, P. P. & CLEAVELAND, S., 2011. Serologic Surveillance of Anthrax in the Serengeti Ecosystem, Tanzania, 1996–2009. Emerging Infectious Disease journal, 17, 387.
- LENSING, H. H. & OEI, H. L., 1984. Een onderzoek naar de werkzaamheid an ontsmettingsmiddelen ten opzichte van miltvuursporen. A study on the efficacy of disinfectants against anthrax spores Tijdschrift voor Diergeneeskunde, 109, 557-563.
- LEPPLA, S. H., 1991. The anthrax toxin complex. In: ALOUF, J. & FREER, J.H. (eds.). Sourcebook of Bacterial Protein Toxins, New York: Academic Press.
- LEPPLA, S. H., 1995. Anthrax toxins. In: MOSS, J., IGLEWSKI, B., VAUGHAN, M. & TU, A.T. (eds.). Bacterial Toxins and Virulence Factors in Disease, Handbook of Natural Toxins. 8, New York: Marcel Dekker.
- LEPPLA, S. H., IVINS, B. E. & EZZELL, J. W., JR., 1985. Anthrax toxin. In: LEIVE, L., (ed.). Microbiology, Washington, D.C, American Society for Microbiology.
- LIGHTFOOT, N. F., SCOTT, R. J. D. & TURNBULL, P. C. B., 1990. Antimicrobial susceptibility of Bacillus anthracis. Salisbury Medical Bulletin Special Supplement, 68, 95-98.
- LINCOLN, R. E. & FISH, D. C., 1970. Anthrax toxin. In: MONTIE, T.C., KADIS SAND AJL, S.J., (eds.). Microbial Toxins, New York: Academic Press.
- LINCOLN, R. E. & RHIAN, M. A., 1950. Pathogenesis as related to physiological state of anthrax spore and cell. In: HALVORSON, H., (ed.). Spores II, Minneapolis: Burgess Publishing Company.
- LINCOLN, R. E., WALKER, J. S., KLEIN, F., ROSENWALD, A. J. & JONES, W. I. J. R., 1967. Value of field data for extrapolation in anthrax. Federation Proceedings, 26, 1558-1562.
- LINDEQUE, P. M., BRAIN, C. & TURNBULL, P. C. B., 1996. A review of anthrax in the Etosha National Park. Salisbury Medical Journal (Special Supplement), 87, 24-26.
- LINDEQUE, P. M., NOWELL, K., PREISSER, T., BRAIN, C. & TURNBULL, P. C. B., 1998. Anthrax in wild cheetahs in the Etosha National Park, Namibia. Proceedings of the ARC-Onderstepoort OIE International Congress with WHO-Cosponsorship on Anthrax, Brucellosis, CBPP, Clostridial and Mycobacterial Diseases, Berg-en Dal, Kruger National Park, 9-15.
- LINDEQUE, P. M. & TURNBULL, P. C. B., 1994. Ecology and epidemiology of anthrax in the Etosha National Park, Namibia. Onderstepoort Journal of Veterinary Research, 61, 71-83.
- LINDSAY, D. R. & SCUDDER, H. I., 1956. Nonbiting flies and disease. Annual Review of Entomology, 1, 323-346.
- LISTA, F., FAGGIONI, G., VALJEVAC, S., CIAMMARUCONI, A., VAISSAIRE, J., LE DOUJET, C., GORGÉ, O., DE SANTIS, R., CARATTOLI, A., CIERVO, A., FASANELLA, A., ORSINI, F., D'AMELIO, R., POURCEL, C., CASSONE, A. & VERGNAUD, G., 2006. Genotyping of Bacillus anthracis strains based on automated capillary 25-loci Multiple Locus Variable-Number Tandem Repeats Analysis. BMC Microbiology, 6(1), 33.
- LITTLE, S. F. & KNUDSON, G. B., 1986. Comparative efficacy of Bacillus anthracis live spore vaccine and protective antigen against anthrax in the guinea-pig. Infection and Immunity, 52, 509-512.
- LIU, D.-L., WEI, J.-C., CHEN, Q.-L., GUO, X.-J., ZHANG, E.-M., HE, L., LIANG, X.-D., MA, G.-Z., ZHOU, T.-C., YIN, W.-W., LIU, W., LIU, K., SHI, Y., JI, J.-J., ZHANG, H.-J., MA, L., ZHANG, F.-X., ZHANG, Z.-K., ZHOU, H., YU, H.-J., KAN, B., XU, J.-G., LIU, F. & LI, W., 2017. Genetic source tracking of an anthrax outbreak in Shaanxi province, China. Infectious Diseases of Poverty, 6, 14. doi 10.1186/s40249-016-0218-6.
- LIVINGSTONE, D., 1857. Missionary Travels and Researches in South Africa.
- LOGAN, N. A. & DE VOS, P., 2015. Bacillus. Bergey’s Manual of Systematics of Archaea and Bacteria, Online © 2015 Bergey’s Manual Trust. This article is © 2009 Bergey’s Manual Trust. doi: 10.1002/9781118960608.gbm00530.
- LYON, D. G., 1973. An outbreak of anthrax at the Chester Zoological Gardens. The Veterinary Record, 92, 334-337.
- MAHO, A., ROSSANO, A., HÄCHLER, H., HOLZER, A., SCHELLING, E., ZINSSTAG, J., HASSANE, M. H., TOGUEBAYE, B. S., AKAKPO, A. J., VAN ERT, M., KEIM, P., KENEFIC, L., FREY, J. & PERRETEN, V., 2006. Antibiotic Susceptibility and Molecular Diversity of Bacillus anthracis Strains in Chad: Detection of a New Phylogenetic Subgroup. Journal of Clinical Microbiology, 44, 3422.
- MAKINO, S., UCHIDA, I., TERAKADO, N., SASAKAWA, C. & YOSHIKAWA, M., 1989. Molecular characterization and protein analysis of the cap region, which is essential for encapsulation in Bacillus anthracis. Journal of Bacteriology, 171, 722–730.
- MAKINO, S., WATARAI, M., CHEUN, H., SHIRAHATA, T. & UCHIDA, I., 2002. Effect of the lower molecular capsule released from the cell surface of Bacillus anthracis on the pathogenesis of anthrax. Journal of Infectious Diseases, 186(2), 227-233.
- MANCHEE, R. J., BROSTER, M. G., ANDERSON, I. S., HENSTRIDGE, R. M. & MELLING, J., 1983. Decontamination of Bacillus anthracis on Gruinard Island. Nature, 303, 239-240.
- MANCHEE, R. J., BROSTER, M. G., MELLING, J., HENSTRIDGE, R. M. & STAGG, A. J., 1981. Bacillus anthracis on Gruinard Island. Nature, 294, 254–255.
- MANCHEE, R. J., BROSTER, M. G., STAGG, A. J., HIBBS, S. E. & PATIENCE, B., 1990. Out of Gruinard Island. Salisbury Medical Bulletin Special Supplement, 68, 17-18.
- MARTIN, G. J. & FRIEDLANDER, A. M., 2010. Bacillus anthracis (anthrax). In: G.L. Mandell, J.E. Bennett and R. Dolin, eds. Mandell, Douglas, and Bennett’s principles and practice of infectious diseases. 7th edition, 2715–25. Philadelphia, Churchill Livingstone.
- MCCONNELL, E. E., TUSTIN, R. C. & DE VOS, V., 1972. Anthrax in an African buffalo (Syncerus caffer) in the Kruger National Park. Journal of the South African Veterinary Medical Association, 43, 181-187.
- MCCULLOUGH, E. C., 1936. Disinfection and Sterilization. Effect of Temperature upon Microbial Life, Philadelphia: Lea and Fabiger.
- MCKENDRICK, A. G., 1940. The dynamics of crowd infections. Edinburgh Medical, 47, 117-136.
- MESELSON, M., GUILLEMIN, J., HUGH-JONES, M., LONGMUIR, A., POPOVA, I., SHELOKOV, A. & YAMPOLSKAYA, O., 1994. The Sverdlovsk anthrax outbreak of 1979. Science Washington, 266, 1202-1208.
- MEYER, K. F., 1915. The Etiology of" Symptomatic Anthrax" in Swine:" Specific Gas-Phlegmon of Hogs". The Journal of Infectious Diseases, 458-496.
- MEYNELL, E. & MEYNELL, G. G., 1964. The roles of serum and carbon dioxide in capsule formation by Bacillus anthracis. Journal of General Microbiology, 34, 153-164.
- MIKESELL, P. & VODKIN, M., 1985. Plasmids of Bacillus anthracis. In: LEIVE, L., (ed.). Microbiology, Washington D.C., American Society for Microbiology.
- MILNE, J. C., FURLONG, D., HANNA, P. C., WALL, J. S. & COLLIERR, J., 1994. Anthrax protective antigen forms oligomers during intoxication of mammalian cells. Journal of Biological Chemistry, 269, 20607-20612.
- MINETT, F. C., 1950. Sporulation and viability of B. anthracis in relation to environmental temperature and humidity. Journal of Comparative Pathology, 60, 161-176.
- MINETT, F. C., 1952. The annual and seasonal incidence of anthrax in various countries. Climatic effects and sources of infection. Bulletin Office Des International Epizootics, 37, 238-300.
- MINETT, F. C. & DHANDA, M. R., 1941. Multiplication of B.anthracis and B. chauvoei in soil and water. The Indian Journal of Veterinary Science and Animal Husbandry, 11, 308-321.
- MITZMAIN, M. B., 1914. Insect transmission of anthrax. Journal of Tropical Medicine and Hygiene, 17, 61-62.
- MOAYERI, M. & LEPPLA, S. H., 2004. The roles of anthrax toxin in pathogenesis. Current Opinion in Microbiology, 7, 19-24.
- MOAYERI, M., LEPPLA, S. H., VRENTAS, C., POMERANTSEV, A. P. & LIU, S., 2015. Anthrax Pathogenesis. Annual Review of Microbiology, 69, 185-208.
- MOFFAT, R., 1842. Missionary Labours and Scenes in Southern Africa. London: John Snow.
- MONGOH, M. N., DYER, N. W., STOLTENOW, C. L. & KHAITSA, M. L., 2008. Risk factors associated with anthrax outbreak in animals in North Dakota, 2005: A retrospective case-control study. Public Health Reports, 123(3), 352-9.
- MORRIS, H., 1920. Some carriers of anthrax infection. Journal of the American Veterinary Medical Association, 56, 606-608.
- MORRIS, L. R., PROFFITT, K. M., ASHER, V. & BLACKBURN, J. K., 2016. Elk resource selection and implications for anthrax management in Montana. The Journal of Wildlife Management, 80(2), 235-44.
- MULLINS, J. C., GAROFOLO, G., VAN ERT, M., FASANELLA, A., LUKHNOVA, L., HUGH-JONES, M. E. & BLACKBURN, J. K., 2013. Ecological Niche Modeling of Bacillus anthracis on Three Continents: Evidence for Genetic-Ecological Divergence? PLOS ONE, 8, e72451.
- MUORIA, P. K., MURUTHI, P., KARIUKI, W. K., HASSAN, B. A., MIJELE, D. & OGUGE, N. O., 2007. Anthrax outbreak among Grevy's zebra (Equus grevyi) in Samburu, Kenya. African Journal of Ecology, 45, 483-9.
- MURPHY, T. D., LA BOCCETTA, A. C. & LOCKWOOD, J. S., 1944. Treatment of human anthrax with penicillin: Report of three cases. Journal of the American Medical Association, 126, 948-950.
- NARASIMHAM, C. V., 1954. An interesting outbreak of anthrax. Indian Veterinary Journal, 30, 512-514.
- NDUMNEGO, O. C., CRAFFORD, J., BEYER, W. & VAN HEERDEN, H., 2013. Quantitative anti-PA IgG ELISA; assessment and comparability with the anthrax toxin neutralization assay in goats. BMC Veterinary Research, 9, 265.
- NDUMNEGO, O. C., KÖHLER, S. M., CRAFFORD, J., VAN HEERDEN, H. & BEYER, W., 2016. Comparative analysis of the immunologic response induced by the Sterne 34F2 live spore Bacillus anthracis vaccine in a ruminant model. Veterinary Immunology and Immunopathology, 178, 14-21.
- NDYABAHINDUKA, D. G. K., CHU, L. H., ABDOU, A. H. & GAIFUBA, J. K., 1984. An outbreak of gastrointestinal anthrax. Annali dell Instituto Superiore di Sanita, 20, 205-208.
- NEW, D., ELKIN, B., ARMSTRONG, T. & EPP, T., 2017. Anthrax in the Mackenzie Wood Bison (Bison bison athabascae) Population: 2012 Anthrax Outbreak and Historical Exposure in Nonoutbreak Years. Journal of Wildlife Diseases, 53(4), 769-780. doi: 10.7589/2016-11-257.
- NIESCHULZ, O., 1928. Enkele miltvuuroverbrengingsproeven met tabaniden, musciden, en muskieten. NederlandsIndische Bladin voor Diergeneeskunde, 40, 355-377.
- NISIHARA, T., ICHIKAWA, T. & KONDO, M., 1985. Location of elements in dipocolinic acid requirement for l alanine induced germination of Bacillus cereus BIS-59 spores. Microbios, 44, 33-44.
- NORDBERG, B. K., SCHMITERLOW, G. G. & HANSEN, N. J., 1961. Pathological investigations into the terminal course of experimental anthrax in the rabbit. Acta Pathologica et Microbiologica Scandanavia, 53, 295-318.
- ODENDAAL, M. W., PIETERSON, P. M. & DE VOS, V., 1991. The antibiotic sensitivity patterns of Bacillus anthracis isolated from the Kruger National Park. Onderstepoort Journal of Veterinary Research, 58, 17-19.
- OELOFSEN, J., 1969. Cited by: PIENAAR U. DE V., 1973. The capture and restraint of wild herbivores by mechanical methods. In: YOUNG, E., (ed.). The Capture and Care of Wild Animals, 91–99. Cape Town and Pretoria: Human & Rousseau.
- OIE, 2017. Office International Des Epizooties. http://www.oie.int/fileadmin/Home/eng/Health_standards/tahm/2.01.01_ANTHRAX.pdf.
- OLSUFEV, N. G. & LELER, P. P., 1935. On the importance of tabanids in the spread of anthrax. Abstract in Reviews of Applied Entomology(1936), 24, 177-179.
- OWEN, M. P., SCHAUWERS, W., HUGH-JONES, M. E., KIERNAN, J. A., TURNBULL, P. C. B. & BEYER, W., March 2013. A simple, reliable M'Fadyean stain for visualizing the Bacillus anthracis capsule. Journal of Microbiological Methods, 92, 264-269.
- PALAZZO, L., CARLO, E., SANTAGADA, G., SERRECCHIA, L., ACETI, A., GUARINO, A., ADONE, R. & FASANELLA, A., 2012. Recent Epidemic-Like Anthrax Outbreaks in Italy: What Are the Probable Causes? Open Journal of Veterinary Medicine, 2(2), 74-76. doi: 10.4236/ojvm.2012.22012.
- PARRY, J. M., TURNBULL, P. C. B. & GIBSON, R. J., 1983. Atlas of Bacillus Species, London: Wolfe Medical Publications Ltd.
- PASTEUR, L., 1881. De l’attenuation des virus et de leur retour à la virulence (Attenuation of viruses and their return to virulence). Comptes Rendus de l’Academie des Sciences, 92, 429-435.
- PEZARD, C., BERCHE, P. & MOCK, M., 1991. Contribution of individual toxin components to virulence of Bacillus anthracis. Infection and Immunity, 59, 3472–3477.
- PHASWANA, P. H., NDUMNEGO, O. C., KOEHLER, S. M., BEYER, W., CRAFFORD, J. E. & VAN HEERDEN, H., 2017. Use of the mice passive protection test to evaluate the humoral response in goats vaccinated with Sterne 34F2 live spore vaccine. Veterinary Research, 48, 46.
- PIENAAR, U. & DE, V., 1973. The capture and restraint of wild herbivores by mechanised methods. In: YOUNG, E., (ed.). The Capture and Care of Wild Animals, Cape Town, Pretoria: Human & Rousseau.
- PIENAAR, U. D. V., 1967. Epidemiology of anthrax in wild animals and the control of anthrax epizootics in the KNP, South Africa. Federation Proceedings, 26, 1496-1501.
- PILO, P. & FREY, J., 27 May 2011. Bacillus anthracis: molecular taxonomy, population genetics, phylogeny and patho-evolution. Infection, Genetics and Evolution: Journal of Molecular Epidemiology and Evolutionary Genetics in Infectious Diseases, 11(6), 1218-1224.
- PITT, M. L., LITTLE, S. F., IVINS, B. E., FELLOWS, P., BARTH, J., HEWETSON, J., GIBBS, P., DERTZBAUGH, M. & FRIEDLANDER, A. M., 2001. In vitro correlate of immunity in a rabbit model of inhalational anthrax. Vaccine, 19(32), 4768-4773.
- PLOWRIGHT, W., 1982. The effects of rinderpest and rinderpest control on wildlife in Africa. In: EDWARDS, M.A. & MCDONNELL, U., (eds.). Animal Diseases in Relation to Animal Conservation, Symposium of the Zoological Society of London, 50, 1–58. London: Academic Press.
- POMBO, M., BERTHOLD, I., GINGRICH, E., JARAMILLO, M., LEEF, M., SIROTA, L., HSU, H. & ARCINIEGA, J., 2004. Validation of an anti-PA-ELISA for the potency testing of anthrax vaccine in mice. Biologicals, 32, 157-163.
- POSNANSKY, M., 1966. Prelude to East African History — a Collection of Papers given at the First East African Vacation School in Pre-European African History and Archaeology in December 1962. Oxford: Oxford University Press.
- PROOM, H. & KNIGHT, B. C. J. G., 1955. The minimal nutritional requirements of some species in the genus Bacillus. Journal of General Microbiology, 13, 474-480.
- PROVOST, A. & TROUETTE, M., 1957. Reflexions sur quelques cas de charbon bacteridien (cryptique) chez des bovins. Revue d’elevage et de Medecine Veterinaire des Pays Tropicaux, 10, 25-26.
- PUGH, A. O. & DAVIES, J. C. A., 1990. Human anthrax in Zimbabwe. Salisbury Medical Bulletin Special Supplement, 68, 32-33.
- REDMOND, C., HALL, G. A., TURNBULL, P. C. B. & GILLGAN, J. S., 1997. Experimentally assessed public health risks associated with pigs from farms experiencing anthrax. The Veterinary Record, 141, 244-247.
- REDMOND, C. H. G. A., GREEN, M. & TURNBULL, P. C. B., 1996. Bacteriology, serology and pathology of experimental anthrax in pigs. Salisbury Medical Bulletin Special Supplement, 87, 79-82.
- REVICH, B. A. & PODOLNAYA, M. A., 2011. Thawing of permafrost may disturb historic cattle burial grounds in East Siberia. Global Health Action, 4, 10.3402/gha.v4i0.8482.
- RICH, V., 1980. Incident at military village no 19. Nature, 284, 294.
- ROBILLARD, N. K., KOEHLER, T. M., MURRAY, R. & THORNE, C. B., 1983. Effects of plasmid loss on the physiology of Bacillus anthracis. Abstracts of the Annual Meeting of the American Society of Microbiology, 83, 115.
- ROLOFF, H., GLÖCKNER, P., MISTELE, P. & BÖHM, R., 1996. The taxonomic relationship between B. anthracis and the B. cereus group, investigated by DNA-DNA hybridization and DNA amplification fingerprinting (DAF). Salisbury Medical Bulletin (Special Supplement), 87, 38-39.
- ROSS, J. M., 1957. The pathogenesis of anthrax following the administration of spores by the respiratory route. Journal of Pathology and Bacteriology, 73, 485-494.
- ROULI, L., MBENGUE, M., ROBERT, C., NDIAYE, M., LA SCOLA, B. & RAOULT, D., 2014. Genomic analysis of three African strains of Bacillus anthracis demonstrates that they are part of the clonal expansion of an exclusively pathogenic bacterium. New Microbes and New Infections, 2(6), 161-9.
- SAHL, J. W., PEARSON, T., OKINAKA, R., SCHUPP, J. M., GILLECE, J. D., HEATON, H., BIRDSELL, D., HEPP, C., FOFANOV, V. & NOSEDA, R., 2016. A Bacillus anthracis genome sequence from the Sverdlovsk 1979 autopsy specimens. MBio, 7, e01501-16.
- SAILE, E. & KOEHLER, T. M., 2002. Control of anthrax toxin gene expression by the transition state regulator abrB. Journal of Bacteriology, 184(2), 370-80.
- SALB, A., STEPHEN, C., RIBBLE, C. & ELKIN, B., 2014. Descriptive epidemiology of detected anthrax outbreaks in wild wood Bison (Bison bison athabascae) in northern canada, 1962–2008. Journal of Wildlife Diseases, 50, 459-468.
- SAUNDERS, J. E., 1939. Cited by STABLEFORTH, A.W. & GALLOWAY, I.A. Infectious Diseases of Animals, Diseases Due to Bacteria. Vol. I, London: Butterworths Scientific Publications.
- SCHLINGMAN, A. S., DEVLIN, H. B., WRIGHT, G. G., MAINE, R. J. & MANNLNG, M., 1956. Immunizing activity of alum-precipitated protective antigen of Bacillus anthracis in cattle, sheep and swine. American Journal of Veterinary Research, 17, 256-261.
- SCHMITT, K. & ZACCHIA, N. A., 2012. Total decontamination cost of the anthrax letter attacks. Biosecurity and Bioterrorism: Biodefense Strategy Practice, and Science, 10(1), doi: 10.1089/bsp.2010.0053.
- SCHUCH, R. & FISCHETTI, V. A., 2009. The secret life of the anthrax agent Bacillus anthracis: Bacteriophage-mediated ecological adaptations. PLOS One, 4(8), e6532.
- SCHUCH, R., PELZEK, A. J., KAN, S. & FISCHETTI, V. A., 2010. Prevalence of Bacillus anthracis-like organisms and bacteriophages in the intestinal tract of the earthworm Eisenia fetida. Applied and Environmental Microbiology, 76(7), 2286-94. doi: 10.1128/AEM.02518-09.
- SEDDON, H. R., 1965. Diseases of domestic animals in Australia. Bacterial Diseases, Vol I 2nd edition, Commonwealth of Australia Department of Health.
- SEN, S. K. & MINETT, F. C., 1944. Experiments on the transmission of anthrax through flies. Indian Journal of Veterinary Science and Animal Husbandry, 14, 149-158.
- SETLOW, P., 2007. I will survive: DNA protection in bacterial spores. Trends in Microbiology, 15(4), 172-80.
- SHIFERAW, F., ABDITCHO, S., GOPILO, A. & LAURENSON, M., 2002. Anthrax outbreak in Mago National Park, southern Ethiopia. Veterinary Record, 150, 318-20.
- SHLYAKHOV, E. N. & RUBINSTEIN, E., 1994. Human live anthrax vaccine in the former USSR. Vaccine, 12, 727-730.
- SHREWSBURY, J. F. D. & BARSON, G. F. A., 1952. A bacteriological study of the house sparrow, Passer domesticus domesticus. Journal of Pathology and Bacteriology, 64, 605-618.
- SIAMUDAALA, V. M., BWALYA, J. M., MUNANG'ANDU, H. M., SINYANGWE, P. G., BANDA, F., MWEENE, A. S., TAKADA, A. & KIDA, H., 2006. Ecology and epidemiology of anthrax in cattle and humans in Zambia. Japanese Journal of Veterinary Research, 54, 15-23.
- SIMONSON, T. S., OKINAKA, R. T., WANG, B., EASTERDAY, W. R., HUYNH, L., U'REN, J. M., DUKERICH, M., ZANECKI, S. R., KENEFIC, L. J., BEAUDRY, J., SCHUPP, J. M., PEARSON, T., WAGNER, D. M., HOFFMASTER, A., RAVEL, J. & KEIM, P., 2009. Bacillus anthracis in China and its relationship to worldwide lineages. BMC Microbiology, 9(1), 71.
- SIRISANTHANA, T., NAVACHAREON, N., THARAVICHITKUL, P., SIRISANTHANA, V. & BROWN, A. E., 1984. Outbreak of oral-oropharyngeal anthrax: An unusual manifestation of human infection with Bacillus anthracis from beef. American Journal of Tropical Medicine and Hygiene, 33, 144-150.
- SMITH, G. & FURTHER, G. S., 1941. Observations on the longevity of dry spores of B. anthracis. Journal of Hygiene, 41, 5-6.
- SMITH, H., 1990. Anthrax, clinical manifestations and pathogenesis: Much unknown and much just forgotten. Salisbury Medical Bulletin Special Supplement, 68, 31.
- SMITH, H. & KEPPIE, J., 1962. The terminal phase of anthrax. British Journal of Experimental Pathology, 43, 684-686.
- SMITH, H. & STONER, H. B., 1956. Anthrax toxic complex. Federation Proceedings, 26, 1554-1557.
- SMITH, K. L., DE VOS, V., BRYDEN, H., PRICE, L. B., HUGH-JONES, M. E. & KEIM, P., 2000. Bacillus anthracis diversity in Kruger National Park. Journal of Clinical Microbiology, 38(10), 3780-3784.
- SMITH, K. L., DE, V. V., BRYDEN, H., HUGH-JONES, M., KEIM, P. P. L. B., KLEVYTSKA, A. & SCHOLL, D. T., 1998. Meso- and macro-ecology of anthrax in southern Africa: Origin and environment. Third International Conference on Anthrax, Plymouth University, Plymouth, UK.
- SMITH, N. R., GORDON, R. E. & CLARK, F. E., 1946. Aerobic mesophilic spore-forming bacterial. United States Department of Agriculture, Miscellaneous Publication, 559.
- SMITH, N. R., GORDON, R. E. & CLARK, F. E., 1952. Aerobic spore-forming bacteria. United States Department of Agriculture, Agriculture Monograph, 16.
- SMITHCORS, J. F., 1957. Evolution of the Veterinary Art. Kansas City, Missouri, Veterinary Medicine Publishing Co.
- SMYTH, H. F. & HIGGINS, W. D., 1945. Anthrax in the United States. Report of the committee on industrial anthrax American Journal of Public Health, 35, 850.
- SOBERNHEIM, G., 1931. Handbuch der Pathogen Mikroorganismen. Jena, Berlin, Vienna: Gustav Fischer Urban und Schwarzenberg.
- SOBERNHEIM, G. & MURATA, H., 1924. Vergleichende Untersuchungen über die Bedeutung des Infektionsmodus bei der experimentellen Milzbrandinfektion. Zeitschrift für Hygiene und Infektionskrankheiten, 103, 691-698.
- SOLTYS, M. A., 1948. Anthrax in a laboratory worker, with observations on the possible source infection. The Journal of Pathology and Bacteriology, 60, 253-257.
- STANLEY, J. L. & SMITH, H., 1961. Purification of Factor I and recognition of a third factor of the anthrax toxin. Journal of General Bacteriology, 26, 49-63.
- STASTNA, J. & VINTER, V., 1970. Spores of microorganisms XX111. Interdependence of intra- and extracellular levels of calcium: Its effects on the germination of bacterial spores in different media. Folia Microbiologica, 15, 103-110.
- STEIN, C. D., 1945. The history and distribution of anthrax in livestock in the USA. Veterinary Medicine and Small Animal Clinician, 40, 340-349.
- STEIN, C. D., 1947. Some observations on the tenacity of Bacillus anthracis. Veterinary Medicine, 42, 13-22.
- STEIN, C. D., 1948. Incidence of anthrax in livestock during 1945, 1946 and 1947 with special reference to control measures in the various states. Veterinary Medicine, 43, 463-469.
- STEIN, C. D., 1955. Anthrax. Farmers Bulletin, 1736, 1-14.
- STEIN, C. D. & ROGERS, H., 1945. Observations on the resistance of anthrax spores to heat. Veterinary Medicine, 40, 406-410.
- STEIN, C. D. & VAN NESS, G. B., 1955. A ten year survey of anthrax in livestock with special reference to outbreaks in 1954. Veterinary Medicine, 50, 579.
- STEPHEN, J., 1981. Anthrax toxin. International Encyclopedia of Pharmacology and Therapeutics, 119, 381-395.
- STERNE, M., 1937. The effects of different carbon dioxide concentrations on the growth of virulent anthrax strains. Pathogenicity and immunity tests on guinea pigs and sheep with anthrax variants derived from virulent strains. Onderstepoort Journal of Veterinary Science and Animal Industry, 9, 49-67.
- STERNE, M., 1937. Variation in Bacillus anthracis. Onderstepoort Journal of Veterinary Science and Animal Industry, 8, 271-349.
- STERNE, M., 1939. The use of anthrax vaccines prepared avirulent (uncapsulated) variants of Bacillus anthracis. Onderstepoort Journal of Veterinary Science and Animal Industry, 13, 307-312.
- STERNE, M., 1959. Anthrax. In: STABLEFORTH, A.W. & GALLOWAY, I.A., (eds.). Infectious Diseases of Animals. Diseases due to Bacteria, 1, London: Butterworths Scientific Publications.
- STERNE, M., 1967. Distribution and economic importance of anthrax. Federation Proceedings, 26, 1493-1495.
- STERNE, M., ROBINSON, E. M. & NICOL, J., 1939. The use of saponin spore vaccine for inoculation against anthrax in South Africa. Onderstepoort Journal of Veterinary Science and Animal Industry, 12, 279-302.
- STERNE, M. N. J. & LAMBRECHTS, M. C., 1942. The effect of large scale active immunization against anthrax. Journal of the South African Veterinary Medical Association, 13, 53-63.
- STERNE, M. N. J. & LAMBRECHTS, M. C., 1945. Field results with avirulent anthrax vaccine. Journal of South African Veterinary Medical Association, 16, 12-13.
- STILES, G. W., 1944. Isolation of the Bacillus anthracis from spinose ear ticks Ornithodorus megnini. American Journal of Veterinary Research, 5, 318-319.
- STOCKMAN, S., 1905. Anthrax. Annual Report of the Department of Agriculture, Transvaal.
- STOCKMAN, S., 1911. The epizootiology of anthrax. Journal of Comparative Pathology and Therapeutics, 24, 97-108.
- SUSSMAN, A. S. & HALVORSON, H. O., 1966. Spores, their dormancy and germination. New York: Harper & Row.
- SUTHERLAND, M. D., THORKILDSON, P., PARKS, S. D. & KOZEL, T. R., 2008. In vivo fate and distribution of poly-γ-d-glutamic acid, the capsular antigen from Bacillus anthracis. Infection and Immunity, 76(3), 899-906.
- TAFT, S. & HINES, S., 2012. Benchmark dose analysis for Bacillus anthracis inhalation exposures in the nonhuman primate. Risk Analysis, 32(10), 1750-68.
- TAMBORRINI, M., BAUER, M., BOLZ, M., MAHO, A., OBERLI, M. A., WERZ, D. B., SCHELLING, E., ZINSSTAG, J., SEEBERGER, P. H., FREY, J. & PLUSCHKE, G., 2011. Identification of an African Bacillus anthracis lineage that lacks expression of the spore surface-associated anthrose-containing oligosaccharide. Journal of bacteriology, 193, 3506-3511.
- THORNE, C. B., GOMEZ, C. G. & HOUSEWRIGHT, R. D., 1952. Synthesis of glutamic acid and glutamyl polypeptide by Bacillus anthracis. Journal of Bacteriology, 63, 363.
- TIGERTT, W. D., 1980. Anthrax. William Smith Greenfield, Professor Superintendent, The Brown Animal Sanitory Institution London, England UK 1878–1881. The priority due to him for the production of the lst vaccine against anthrax. Journal of Hygiene, 85, 415–420.
- TITBALL, R. W. & MANCHEE, R. J., 1987. Factors affecting the germination of spores of Bacillus anthracis. Journal of Applied Bacteriology, 62, 269- 274.
- TITBALL, R. W., TURNBULL, P. C. B. & HUTSON, R. A., 1991. The monitoring and detection of Bacillus anthracis in the environment. Journal of Applied Bacteriology Sumposium Supplement, 70, 9S-18S.
- TOSCHKOFF, A. & VELJANOV, D., 1970. Sporulation und Virulenz von Bacillus anthracis in geöffneten und nicht geöffneten Tierleichen. Archiv für Experimentelle Veterinärmedizin, 24, 1153-1160.
- TURELL, M. J. & KNUDSON, G. B., 1987. Mechanical transmission of Bacillus anthracis by stable flies (Stomoxys calcitrans) and mosquitoes (Aedes aegypti and Aedes taeniorhynchus). Infection and Immunity, 55, 1859-1861.
- TURNBULL, P., 2008. Anthrax in humans and animals. World Organisation for Animal Health, 4th edition,
- TURNBULL, P. C., HUTSON, R. A., WARD, M. J., JONES, M. N., QUINN, C. P., FINNIE, N. J., DUGGLEBY, C. J., KRAMER, J. M. & MELLING, J., 1992. Bacillus anthracis but not always anthrax. Journal of Applied Microbiology, 72(1),
- TURNBULL, P. C. B., 1986. Thoroughly modern anthrax. Bureau of Hygiene and Tropical Disease Abstracts on Hygiene and Tropical Diseases, 61, 1-13.
- TURNBULL, P. C. B., 1990. Anthrax. In: Principles of Bacteriology. Virology and Immunity, 8th edition. London: Arnold, 365-379.
- TURNBULL, P. C. B., 1990. Terminal bacterial and toxin levels in blood of guinea-pigs dying of anthrax. Salisbury Medical Bulletin Special Supplement, 68, 53-55.
- TURNBULL, P. C. B., 1998. Anthrax in sub-Saharan Africa. Is ‘problem’ the appropriate term and what can modern science contribute? Proceedings of the ARC-Onderstepoort OIE International Congress with WHO-Cosponsorship on Anthrax, Brucellosis, CBPP, Clostridial and Mycobacterial Diseases, Berg-en Dal, Kruger National Park, 2.
- TURNBULL, P. C. B., BELL, R. H. V., SAIGAWA, K., MUNYENYEMBE, F. E. C., MULENGA, C. K. & MAKALA, L. H. C., 1991. Anthrax in wildlife in the Luangwa Valley, Zambia. The Veterinary Record, 128, 399-403.
- TURNBULL, P. C. B., BÖHM, R., COSIVI, O., DOGANAY, M., HUGH-JONES, M., JOSHU, D. D., LALITHA, M. K. & DE VOS, V., 1998. Guidelines for the Surveillance and Control of Anthrax in Humans and Animals. 3rd edition. World Health Organization, Department of Communicable Disease Surveillance and Response. Who/EMC/ZDI/98.6.
- TURNBULL, P. C. B., DOGANAY, M., LINDEQUE, P. M., AYGEN, B. & MCLAUGHLIN, J., 1992. Serology and anthrax in humans, livestock and Etosha National Park wildlife. Epidemiology and Infection, 108, 299-313.
- TURNBULL, P. C. B., FRAWLEY, D. A. & BULL, R. L., 2007. Heat activation/shock temperatures for Bacillus anthracis spores and the issue of spore plate counts versus true numbers of spores. Journal of Microbiological Methods, 68(2), 353-7.
- TURNBULL, P. C. B., JACKSON, P. J., HILL, K. K., KOLSTO, A.-B., KEIM, P. & BEECHER, D. J., 2001. Longstanding taxonomic enigmas with the ‘Bacillus cereus group’ are on the verge of being resolved by far-reaching molecular developments. Forecasts on the possible outcome by an ad hoc team. In: BERKELEY, R.C.W., HEYNDRICKX, M., LOGAN, N.A., DE VOLS, P., (eds). Applications and Systematics of Bacillus and Relatives, Blackwell Science, Oxford, in press.
- TURNBULL, P. C. B., LINDEQUE, P. M., LE ROUX, J., BENNETT, A. M. & PARKS, S. R., 1998. Airborne movement of anthrax spores from carcass sites in the Etosha National Park, Namibia. Journal of Applied Microbiology, 84, 667-676.
- TURNBULL, P. C. B., P, Q. C., HEWSON, M. C., STOCKBRIDGE, M. C. & MELLING, J., 1990. Protection conferred by microbially supplemented UK and purified PA vaccine. Salisbury Medical Bulletin Special Supplement, 68, 89-91.
- TURNER, M., 1980. Anthrax in humans in Zimbabwe. Central African Journal of Medicine, 26, 160-161.
- TURNER, W., KAUSRUD, K., KRISHNAPPA, Y., CROMSIGT, J., GANZ, H., MAPAURE, I. & ET AL., 2014. Fatal attraction: vegetation responses to nutrient inputs attract foraging herbivores to infectious anthrax carcass sites. Proceedings of the Royal Society B: Biological Sciences, 281, 20141785.
- TURNER, W. C., IMOLOGHOME, P., HAVARUA, Z., KAAYA, G. P., MFUNE, J. K. E., MPOFU, I. D. T. & GETZ, W. M., 2013. Soil ingestion, nutrition and the seasonality of anthrax in herbivores of Etosha National Park. Ecosphere, 4(1), art13.
- TURNER, W. C., KAUSRUD, K. L., BEYER, W., EASTERDAY, W. R., BARANDONGO, Z. R., BLASCHKE, E., CLOETE, C. C., LAZAK, J., VAN ERT, M. N. & GANZ, H. H., 2016. Lethal exposure: an integrated approach to pathogen transmission via environmental reservoirs. Scientific Reports, 6, 27311.
- TURNER, W. C., KAUSRUD, K. L., KRISHNAPPA, Y. S., CROMSIGT, J. P. G. M., GANZ, H. H., MAPAURE, I., CLOETE, C. C., HAVARUA, Z., KÜSTERS, M., GETZ, W. M. & STENSETH, N. C., 2014. Fatal attraction: vegetation responses to nutrient inputs attract herbivores to infectious anthrax carcass sites. Proceedings of the Royal Society B: Biological Sciences, 281, 1795.
- TWINING, D. T., 1981. Biological warfare opens Pandora’s box in Sverdlovsk anthrax outbreak. Air Force US Magazine, 64, 124-128.
- VAN DEN BOSCH, C., 1996. Recalling an outbreak of gastrointestinal anthrax in northern Kenya. Salisbury Medical Bulletin (Special supplement), 87, 139.
- VAN ERT, M. N., EASTERDAY, W. R., HUYNH, L. Y., OKINAKA, R. T., HUGH-JONES, M. E., RAVEL, J., ZANECKI, S. R., PEARSON, T., SIMONSON, T. S., U'REN, J. M., KACHUR, S. M., LEADEM-DOUGHERTY, R. R., RHOTON, S. D., ZINSER, G., FARLOW, J., COKER, P. R., SMITH, K. L., WANG, B., KENEFIC, L. J., FRASER-LIGGETT, C. M., WAGNER, D. M. & KEIM, P., 2007. Global genetic population structure of Bacillus anthracis. PLOS One, 2(5), e461.
- VAN NESS, G. B., 1959. Soil relationship in the Oklahoma-Kansas anthrax outbreak of 1957. Journal of Soil and Water Conservation, 14, 70-71.
- VAN NESS, G. B., 1971. Ecology of anthrax. Science, 172, 1303-1307.
- VASILEVA, V. M., 1958. study of soil bacteria as antagonists of anthrax bacilli. Sbornik Nanchmykh Trudov Lvovskii Zooveterinarnyi Institut, 9, 149-153.
- VILJOEN, P. R., CURSON, H. H. & FOURIE, P. J. J., 1928. Anthrax in South Africa. 13th and 14th Reports of the Director of Veterinary Education and Research, 431-528.
- WADE, N., 1980. Death at Sverdlovski: A critical diagnosis. An anthrax outbreak Science, 209, 1501-1502.
- WAFULA, M. M., PATRICK, A. & CHARLES, T., 2007. Managing the 2004/05 anthrax outbreak in Queen Elizabeth and Lake Mburo National Parks, Uganda. African Journal of Ecology, 46(1), 24-31.
- WALKER, J. S., KLEIN, F., LINCOLN, R. E. & FERNELIUS, A. L., 1967. Temperature response in animals infected with Bacillus anthracis. Journal of Bacteriology, 93, 552-556.
- WALKER, J. S., KLEIN, F., LINCOLN, R. E. & FERNELIUS, A. L., 1967. A unique defense mechanism against anthrax demonstrated in dwarf swine. Journal of Bacteriology, 93, 2031-2032.
- WALKER, J. S., LINCOLN, R. E. & KLEIN, F., 1967. Pathophysiological and biochemical changes in anthrax. Federation Proceedings, 26, 1539-1544.
- WARD, M. K., MCGANN, V. G., HOGGE, A. L., HUFF, M. L., KANODE, R. G. & ROBERTS, E. O., 1965. Studies on anthrax infections in immunized guinea pigs. The Journal of Infectious Diseases, 115, 59-67.
- WATSON, A. & KEIR, D., 1994. Information on which to base assessments of risk from environments contaminated with anthrax spores. Epidemiology and Infection, 113, 479-490.
- WEAVER, R. E., BRACHMAN, P. S. & FEELEY, J. C., Anthrax. In: BODILY, H.L., UPDIKE, E.L. & MASON, J.O., (eds). Diagnostic Procedures for Bacterial, Mycotic and Parasitic Infections, 5th edition, New York: The American Public Health Association Inc.
- WEBSTER, A., 1973. Inhibiting effect of antibiotics on anthrax vaccination. Australian Veterinary Journal, 49, 545.
- WELKOS, S., 1991. Plasmid-associated virulence factors of non-toxigenic (pX01−) Bacillus anthracis. Microbial Pathogenesis, 10(3), 183-198.
- WELKOS, S., LITTLE, S., FRIEDLANDER, A., FRITZ, D. & FELLOWS, P., 2001. The role of antibodies to Bacillus anthracis and anthrax toxin components in inhibiting the early stages of infection by anthrax spores. Microbiology, 147(6), 1677-1685.
- WELKOS, S. L., BECKER, D., FRIEDLANDER, A. & TROTTER, R., 1990. Pathogenesis and host resistance to Bacillus anthracis: A mouse model. Salisbury Medical Bulletin Special Supplement, 68, 49-52.
- WELKOS, S. L. & FRIEDLANDER, A. M., 1988. Pathogenesis and genetic control of resistance to the Sterne strain of Bacillus anthracis. Microbial Pathogenesis, 4, 53-69.
- WELKOS, S. L., KENNET, T. J. & GIBBS, P. H., 1986. Differences in susceptibility of inbred mice to Bacillus anthracis. Infection and Immunity, 51, 795-800.
- WELKOS, S. L., TROTTER, R. W., BECKER, D. M. & NELSON, G. O., 1989. Resistance to the Sterne strain of B. anthracis phagocytic cell response of resistant and susceptible mice. Microbial Pathogenesis, 7, 15-35.
- WHITFORD, H. W., 1978. Factors affecting the laboratory diagnosis of anthrax. Journal of the American Veterinary Medical Association, 173, 1467-1469.
- WHITFORD, H. W., 1979. Anthrax. In: STEELE, J. H., (ed.). CRC Handbook Series in Zoonoses, Section A: Bacterial, Rickettsial and Mycotic Diseases. Boca Raton, Florida: CRC Press Inc., 1.
- WHITFORD, H. W., 1987. A Guide to the Diagnosis, Treatment and Prevention of Anthrax, World Health Organization.
- WHO, 1967. Requirements for Anthrax Spore Vaccine (Live for Veterinary Use). (Requirements for Biological Substances No. 13). World Health Organization Technical Report Series, 361,
- WHO, 2008. Anthrax in humans and animals. 4th edItion, Turnbull PCB, editor. Geneva, Switzerland: World Health Organization, World Organisation for Animal Health, Food and Agriculture Organization of the United Nations.
- WIDDICOMBE, J. G., HUGHES, R. & MAY, A. J., 1956. The role of the lymphatic system in the pathogenesis of anthrax. British Journal of Experimental Pathology, 37, 343-349.
- WILLIAMS, N., 1932. Anthrax. Journal of the American Veterinary Medical Association, 81, 9-25.
- WILSON, G. S. & MILES, A. S., 1966. Anthrax. In: Topley and Wilson’s Principles of Bacteriology and Immunity. I. 5th edition, London: Edward Arnold (Publishers) Ltd.
- WILSON, J. B. & RUSSELL, K. E., 1964. Isolation of Bacillus anthracis from soil stored for 60 years. Journal of Bacteriology, 87, 237-238.
- WOLF, J. & BARKER, A. N., 1968. The genus Bacillus: Aids to the identification of the species In: BERKELEY, R.C.W. & GOODFELLOW, M., (eds.). The Aerobic Endospore-forming Bacteria: Classification and Identification, London: Academic Press.
- YOUNG, G. A., JR., R, Z. M. & LINCOLN, R. E., 1946. Respiratory pathogenicity of Bacillus anthracis spores. The Journal of Infectious Diseases, 79, 233-271.
- ZARUBKINSKY, V. S., 1958. Self-purification of soil and water of Bacillus anthracis spores. Sbornik Nanchnykh Institut, 9, 51-58.
- ZIDON, R., GARTI, S., GETZ, W. & SALTZ, D., 2017. Zebra migration strategies and anthrax in Etosha National Park, Namibia. Ecosphere, 8(8), e01925.